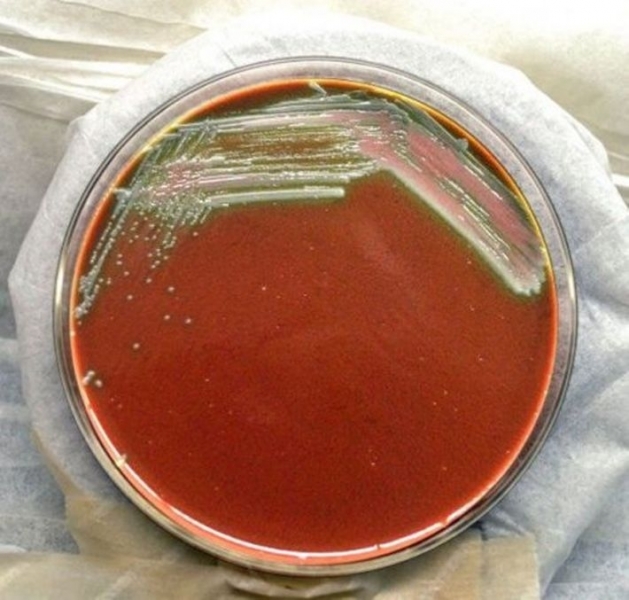

10. Сила

Люди считают себя самыми сильными и властными существами на планете. И хотя наша сила, действительно, выдающаяся, такие крошечные создания, как жуки и муравьи, могут постыдить даже самого сильного тяжелоатлета. Например, навозный жук способен поднять груз, который в 1 141 раз тяжелее его собственного веса! Возможно, максимальное достижение в граммах этого маленького насекомого прозвучит не так уж и впечатляюще. Но если выразить его в эквиваленте человеческих возможностей, жука скарабея можно сравнить с мужчиной, способным поднять целых 73 000 килограммов.
Что касается чистого веса, самыми сильными в мире животными являются африканские слоны. Эти огромные и любвеобильные создания могут перевозить до 9 000 килограммов грузов. Именно такая мощь заключена в их массивных телах. Благодаря десяткам тысяч мышц в туше слона, эти обитатели африканских равнин могут поднимать самые огромные предметы, включая собственных детенышей, и выпивают невероятное количество воды за раз, чтобы выживать в суровых условиях жаркого континента.
Сила мелких насекомых (муравьи и жуки) зависит не от их собственного веса или размера, а от площади поперечного сечения мышц. На практике получается, что чем короче тело живого организма, тем выгоднее соотношение перетаскиваемого груза к массе самого существа.
Выходит, что если удвоить длину тела, поперечное сечение мышц должно увеличиться в 4 раза, а его объем и вес – в 8 раз. Однако более вытянутый (длинный) организм в реальности не может развить пропорционально сильную мышечную систему, чтобы компенсировать утраченную силу.
9. Скорость

В отличие от силовых показателей, в быстроте маленькие существа не могут тягаться с более крупными животными и людьми. В этом качестве себя неплохо проявляют именно более крупные особи.
Например, самый быстрый человек из ныне живущих – Усэйн Болт (Usain Bolt, ямайский легкоатлет). Он является официальным обладателем рекорда мира. Знаменитый олимпиец способен развить скорость до 44,72 километра в час на отрезке в 100 метров. Хотя гепард с легкостью обгонит известного спринтера. Этот грациозный зверь способен разгоняться до 120 километров в час всего за 3 секунды!
Одним из самых скоростных живых существ на планете признан сапсан (птица из семейства соколиных), ведь он способен развивать абсолютно невероятную скорость – 355 километров в час. Эта птица до сих пор конкурирует с самыми современными технологиям, когда-либо созданными людьми. Чтобы охотиться в небе, сапсан должен заныривать за своей добычей с высочайшей скоростью. Своим рекордом птица обязана комбинации тонких вытянутых перьев, форме крыльев и аэродинамичному телу.
Причина такого выдающегося таланта животных проста – им просто необходимо быть быстрыми. Нам – уже нет.
8. Работоспособность

Ни для кого не секрет, что люди – не самые трудолюбивые и производительные обитатели Земли.
Всем нам знакома поговорка «пашет, как пчелка». Некоторые пчелы работают всего несколько часов, но другие способны заниматься своими обязанностями дольше 12 часов без передышки. Рабочие пчелы, ответственные за обустройство улья, заняты делом круглые сутки – и днем, и ночью. Ввиду отсутствия ограничений, связанных с временными и прочими факторами, эти насекомые могут трудиться (например, охлаждать гнезда взмахами своих крыльев) почти весь день с короткими перерывами на приемы пищи.
Муравьи – еще один отличный пример очень работоспособных насекомых. В их сообществе каждый член выполняет свою роль. Одни муравьи защищают свою колонию, другие добывают еду, а третьи устраивают набеги на чужие муравейники и захватывают новые территории. Их труд не просто тяжелый, но и довольно продолжительный.
В конце рабочего дня мы отдыхаем и затем ложимся спать, что в итоге составляет примерно 14 – 16 часов покоя в сутки, а рабочие муравьи отдыхают только 4-5 часов в день. Причем эти неустанные трудяги умудряются растянуть время отдыха на сотни коротких пауз для сна. Однако все это в итоге сокращает продолжительность их жизни.
7. Приспосабливание

Люди за всю историю своего существования адаптировались к жизни в самых всевозможных условиях от испепеляюще жарких пустынь до вечно морозных уголков Земли, где не выживает больше ни один другой зверь. Однако в немалой степени мы зависим от зданий и механизмов, в то время как животные лишены возможности творить что-либо такое же сложное своими «руками». Тем не менее они до сих пор остаются нашими соседями, а некоторые из этих живых существ обитают на нашей Земле намного дольше нас. Как им это удалось?
На адаптацию у некоторых животных ушли миллионы лет. Представьте себе африканское животное, которое не могло прокормить себя, потому что оно буквально не было способно добраться до своей еды. Со временем этот зверь отрастил длинную шею, чтобы добираться до ветвей самых высоких деревьев, а уже сегодня он известен нам как современный жираф.
Классически пример приспосабливания – полет. Пока обезьяны предпочитали прыгать и карабкаться по раскидистым ветвям деревьев, некоторые животные выбрали другой подход и научились летать. Живые существа, которым в силу их природы надо совершать путешествия на особенно длинные дистанции, выжили именно благодаря умению летать. Путешествия по небу позволяют более крупным группам переселяться на более далекие расстояния в самые кратчайшие сроки.
Некоторые ученые переживают, что человеческий вид стал почти не способен на физическую адаптацию и не изменится в течение ближайших нескольких тысяч лет. Из-за технического прогресса мы попросту выпадаем из общей схемы эволюции организмов и естественного отбора. Людям больше нет нужды адаптировать свое тело к изменяющимся условиям окружающего мира. Нам остается надеяться, что через несколько десятков веков остальная живность не ополчится на нас с уже новым набором частей тела и органов чувств.
6. Зрение

Животные видят намного лучше нас. Да, люди создали удивительные оптические приспособления – очки, линзы и даже телескопы, способные показать самые далекие уголки нашей Вселенной.
Но на практике это оборудование не меняет того факта, что животные безо всяких уловок видят намного дальше и четче, чем мы. Человеку больше не нужно выживать посреди широких и открытых местностей. А вот существам, у которых нет доступа к сельскому хозяйству, животноводству и технологиям, все еще необходимо хорошее зрение. Например, птицам нужно засечь свою добычу намного раньше, чем жертва успеет заметить хищника.
Орел – классический образец животного с исключительно острым зрением. Даже самые близорукие орлы видят в 4 раза лучше, чем среднестатистический человек. Самые зрячие орлы превосходят нас в зрительной способности в 8 раз! Известно, что этот величественный хищник может заметить зайца с расстояния целых 5 километров.
5. Слух

Может быть, вы видите лучше летучей мыши, но слух у вас точно намного слабее, чем у этого ночного создания. Летучие мыши слышат так хорошо, что это почти полностью компенсирует их плохое зрение. Когда это животное летит по пещере в полной темноте, оно издает писклявые звуки, которые отражаются от окружающих его тело стен. Зверек использует эту информацию, чтобы понять, где на его пути находятся преграды, и куда лететь не стоит. Такой навык распространен среди многих других живых существ. Его суть состоит в том, что недостаток одного чувства приводит к качественному усилению другого. В случае летучих мышей плохое зрение означает, что их мозг больше занят другими задачами, нежели обработкой сигналов, поступающих через зрительный нерв. В результате они тратят больше ресурсов именно на развитие слуха.
4. Интеллектуальные способности

Люди – уникальные создания. Мы поем, рисуем, пишем, разговариваем на разных языках, изучаем окружающий нас мир и создаем удивительные вещи, включая небоскребы, батискафы и космические корабли. Однако некоторые из братьев наших меньших способны удивить крайне выдающимися умственными способностями.
Например, почтовые голуби. Эти птицы могут преодолеть расстояние в 1770 километров и вернуться назад домой из абсолютно незнакомого им места без какой-либо карты, маяков или GPS. Самое удивительное в их навигационных способностях то, что для ориентирования эти пернатые создания используют железосодержащие магнитные рецепторы, чтобы определять свое географическое местоположение относительно магнитного поля Земли, а также научились считывать уникальные инфразвуковые карты местности. Вы так умеете?
Слоны могут казаться глупыми животными. Но и эти создания могут удивить вас своими недюжинными талантами и навыками. Исследования подтвердили, что слоны создают настоящие каталоги всех членов своей семьи с помощью обоняния и узнают всех своих родственников по запаху, а семья у них большая. Вдобавок по запаху они также способны определить, угрожает ли им человек, и умеют различать цвета нашей одежды.
3. Боевое искусство

Мы привыкли считать, что военное дело – это то, в чем мы особенно преуспели. Всевозможные виды рукопашного боя, развивавшиеся на протяжении многих столетий, технологические приспособления, начиная от мушкетов, и заканчивая современнейшим оружием секретных лабораторий, – все это дает нам громадное преимущество над любыми животными на Земле.
Нам удалось возвести боевое искусство и способы самозащиты на небывалые вершины. Однако царство зверей тоже не так уж и безобидно. Например, в подводной экосистеме кальмары нейтрализуют своих хищников выстрелом чернильной жидкости. Хотя и это не самый выдающийся образец самообороны из мира фауны.
На первый взгляд техасская жабовидная (или рогатая) ящерица выглядит как обычная рептилия из своего подотряда – грубая чешуйчатая кожа и камуфляжный окрас. Но если ее разозлить, вы поймете, как ошибались. Эта ящерица умеет стрелять кровью прямо из своих глаз. Возможно, это не самый действенный способ самозащиты, но сложно отрицать, как далеко зашло это животное в своем желании выжить.
Про ядовитых животных вы точно знаете. Змеи, насекомые и даже некоторые растения способны убить вас, и это всего лишь часть их естества, а не результаты кропотливых лабораторных экспериментов.
2. Общение

Наверное, прямо сейчас вы сидите за компьютером или читаете эту подборку с мобильного телефона. Это удивительные посредники коммуникационного процесса, но им до сих пор не сравниться со старой доброй матушкой-природой.
Горбатки – это очень мелкие насекомые, питающиеся древесным соком. От природы они умеют преобразовывать эту жидкость в нектар. Многие гекконы очень любят это угощение, и в результате сладкий сироп обеспечивает насекомым очень выгодное взаимодействие со своим прямым хищником.
Когда геккон обнаруживает горбатку, он может затребовать от жертвы нектар, для чего рептилия начинает вибрировать головой. Как только послание доходит до находящейся в опасности цикады, она делится своим нектаром, и удовлетворенная ящерица оставляет это насекомое в покое. Неизвестно, как именно эти существа догадались до такой коммуникации, но ученые пришли к выводу, что нектар в этом процессе становится своего рода платой за безопасность.
Муравьи для общения используют феромоны (ароматизированные химические вещества). С помощью специальных рецепторов, напоминающих антенны, эти крошечные насекомые способны распознавать различные запахи в зависимости от их типа и предназначения, и реагируют соответственно полученному «ароматизированному» сообщению. Например, муравей, на которого совершается нападение, может испускать феромон, который учуют тысячи членов его колонии. В результате жертва может оказаться не такой уж и беззащитной, а призванные товарищи не только отобьют члена своего сообщества, но и полностью уничтожат врага.
1. Внешний вид и красота

Люди часто считают представителей других видов отвратительнейшими созданиями. При близком рассмотрении с виду милой бабочки или безобидного муравья многие из вас поморщатся и даже ужаснутся их страшным челюстям и странным глазам. И все же некоторым животным мы способны умилиться больше, чем собственным друзьям или даже своей второй половинке.
Такие зверьки, как цыплята, кролики или котята, не могут не вызывать восторг или даже желание погладить и потискать их пушистые тельца. Ученые считают, что все дело в схожести этих животных с некоторыми чертами человеческих детей – большие глаза, круглые «лица» и небольшое тельце.
Другие создания очаровывают иначе и по другим причинам. Например, голубой дракон (Glaucus atlanticus, вид брюхоногих моллюсков) – настоящее чудо природы. Тело этого морского обитателя имеет 2 разных цвета: одна сторона сливается с мерцающим серебром водной поверхности, а другая походит на морскую бездну синего цвета. Такой окрас в процессе эволюции это животное приобрело в целях самозащиты и камуфляжа, чтобы оставаться незамеченным как можно дольше, как сверху, так и снизу. Вопреки своим скромным размерам голубые драконы могут охотиться на весьма крупную добычу, среди которой бывают даже португальские военные кораблики (вид медузы) и другие брюхоногие. Вероятно, укус Glaucus atlanticus не слабее жала медуз, которыми они питаются.
К великому сожалению, это удивительное создание находится на грани вымирания. Причиной тому выступает несколько факторов, но одно известно точно – без этих красивейших моллюсков мир станет более печальным местом.
]]>




































































































































































































































































































 Когда рождается ребенок, иногда его голова покрыта оболочкой, оставшейся после того, как водный пузырь, в котором находился малыш в утробе, разорвался. Это случается очень редко, один случай на 80 000 новорожденных. В древние времена, если ребенок рождался в такой оболочке, гадалки утверждали, что она может многое рассказать о будущем малыша. Если оболочка была красной, это означало, что ребенок будет жить счастливой жизнью, но, если она была синего цвета, то в будущем следовало ожидать чего-то ужасного.
Когда рождается ребенок, иногда его голова покрыта оболочкой, оставшейся после того, как водный пузырь, в котором находился малыш в утробе, разорвался. Это случается очень редко, один случай на 80 000 новорожденных. В древние времена, если ребенок рождался в такой оболочке, гадалки утверждали, что она может многое рассказать о будущем малыша. Если оболочка была красной, это означало, что ребенок будет жить счастливой жизнью, но, если она была синего цвета, то в будущем следовало ожидать чего-то ужасного.
 В Древней Греции последователи бога Гефеста считали, что могут общаться с ним посредством огня. Подобно хрустальному шару, некоторые люди смотрели в огонь и утверждали, что видят будущее. Гадание по огню подразумевает получение информации, просто наблюдая за пламенем, но многие провидцы делали больше, чем просто смотрели. Форма пламени считалась предсказанием, данным духами относительно хороших или плохих событий в будущем. Если какой-то предмет бросали в огонь, то, как он горел, также служило предсказанием будущего. Если предмет быстро сгорал, не производя при этом много дыма, это означало, что будущее будет хорошим. И наоборот, если предмет трудно разгорался, это считалось очень плохим предзнаменованием, предрекающим ужасную трагедию.
В Древней Греции последователи бога Гефеста считали, что могут общаться с ним посредством огня. Подобно хрустальному шару, некоторые люди смотрели в огонь и утверждали, что видят будущее. Гадание по огню подразумевает получение информации, просто наблюдая за пламенем, но многие провидцы делали больше, чем просто смотрели. Форма пламени считалась предсказанием, данным духами относительно хороших или плохих событий в будущем. Если какой-то предмет бросали в огонь, то, как он горел, также служило предсказанием будущего. Если предмет быстро сгорал, не производя при этом много дыма, это означало, что будущее будет хорошим. И наоборот, если предмет трудно разгорался, это считалось очень плохим предзнаменованием, предрекающим ужасную трагедию. Американские индейцы Чероки обращались к лекарю или «длинному человеку» каждый раз, когда хотели заглянуть в будущее. Вся семья часто посещала длинного человека, который всегда жил у реки. Он произносил заклинание и просил у реки знака, который помог бы узнать о будущем семьи. Если река продолжала безмятежно нести свои воды, и на ее поверхности ничего не происходило, то это означало, что, по крайней мере, в ближайшие 7 лет жизнь будет счастливой и изобильной. Однако, если в этот момент на реке появлялось бревно или даже крошечный лист, это означало, что в ближайшем будущем в семье кто-то умрет.
Американские индейцы Чероки обращались к лекарю или «длинному человеку» каждый раз, когда хотели заглянуть в будущее. Вся семья часто посещала длинного человека, который всегда жил у реки. Он произносил заклинание и просил у реки знака, который помог бы узнать о будущем семьи. Если река продолжала безмятежно нести свои воды, и на ее поверхности ничего не происходило, то это означало, что, по крайней мере, в ближайшие 7 лет жизнь будет счастливой и изобильной. Однако, если в этот момент на реке появлялось бревно или даже крошечный лист, это означало, что в ближайшем будущем в семье кто-то умрет. Во многих культурах поведение животных принималось во внимание как знак будущего. В Древней Греции Александр Великий советовался с провидцем по имени Аристандер. Однажды Александр собирался принести в жертву богам животное в обмен на победу в битве. Внезапно над жертвенным алтарем пролетела большая птица и уронила камень на голову короля. Аристандер был там и интерпретировал этот знак так, что Александр, без сомнения, победит, поэтому нет необходимости убивать жертвенное животное.
Во многих культурах поведение животных принималось во внимание как знак будущего. В Древней Греции Александр Великий советовался с провидцем по имени Аристандер. Однажды Александр собирался принести в жертву богам животное в обмен на победу в битве. Внезапно над жертвенным алтарем пролетела большая птица и уронила камень на голову короля. Аристандер был там и интерпретировал этот знак так, что Александр, без сомнения, победит, поэтому нет необходимости убивать жертвенное животное. Хрустальные шары использовались повсеместно, от цирковых гадалок до разных волшебников, этот предмет помогал экстрасенсам заглянуть в будущее. Правильный термин для этого действа – «провидение», и оно может быть совершено с помощью любой плоской отражающей поверхности, включая зеркала, воду и кристаллы.
Хрустальные шары использовались повсеместно, от цирковых гадалок до разных волшебников, этот предмет помогал экстрасенсам заглянуть в будущее. Правильный термин для этого действа – «провидение», и оно может быть совершено с помощью любой плоской отражающей поверхности, включая зеркала, воду и кристаллы. В Древнем Египте возводились гигантские каменные или металлические статуи с единственной целью – использовать их в ритуалах гадания, чтобы предсказать будущее. Эта практика иногда также упоминается как идолопоклонство или молитва идолам. Главное отличие заключается в том, что статуи были достаточно большими, чтобы стоять посреди городской площади, а идолы – достаточно маленькими, чтобы держать их дома.
В Древнем Египте возводились гигантские каменные или металлические статуи с единственной целью – использовать их в ритуалах гадания, чтобы предсказать будущее. Эта практика иногда также упоминается как идолопоклонство или молитва идолам. Главное отличие заключается в том, что статуи были достаточно большими, чтобы стоять посреди городской площади, а идолы – достаточно маленькими, чтобы держать их дома. В древнем Китае и средневековой Европе гадалки практиковали тассеографию или тассеомантию, которая является искусством чтения чайных листьев. Выпивая чашку чая, заваренного из сухих листьев, смотрят, какой рисунок сформировался из чайных листьев на дне, после того, как в чашке не осталось жидкости. Толкование формы, образованной чайными листьями, очень напоминает тест Роршаха (Rorschach).
В древнем Китае и средневековой Европе гадалки практиковали тассеографию или тассеомантию, которая является искусством чтения чайных листьев. Выпивая чашку чая, заваренного из сухих листьев, смотрят, какой рисунок сформировался из чайных листьев на дне, после того, как в чашке не осталось жидкости. Толкование формы, образованной чайными листьями, очень напоминает тест Роршаха (Rorschach). Основная идея такого способа гадания заключается в том, чтобы получить прогноз относительно будущего, используя предметы, которые могут дать четкие ответы типа «да», «нет», «возможно». Идея была использована несколькими культурами. Гадали, например, с помощью ракушек, палочек, бумаги и даже бобов. Иногда люди использовали маятник, который представлял собой кристалл или иной предмет, подвешенный на веревке. В зависимости от направления, в котором он качался, получали ответ «да» или «нет».
Основная идея такого способа гадания заключается в том, чтобы получить прогноз относительно будущего, используя предметы, которые могут дать четкие ответы типа «да», «нет», «возможно». Идея была использована несколькими культурами. Гадали, например, с помощью ракушек, палочек, бумаги и даже бобов. Иногда люди использовали маятник, который представлял собой кристалл или иной предмет, подвешенный на веревке. В зависимости от направления, в котором он качался, получали ответ «да» или «нет». Ацтеки и инки известны человеческими жертвоприношениями, но они не всегда приносили жертвы исключительно для того, чтобы задобрить богов. «Антропомантия» буквально означает «гадание по человеку». Дети и младенцы приносились в жертву, чтобы по их внутренностям можно было предсказать будущее.
Ацтеки и инки известны человеческими жертвоприношениями, но они не всегда приносили жертвы исключительно для того, чтобы задобрить богов. «Антропомантия» буквально означает «гадание по человеку». Дети и младенцы приносились в жертву, чтобы по их внутренностям можно было предсказать будущее. В древней ирландской традиции для гадания использовали небо, звезды и ветер. Сегодня это называется хаомантией и охватывает большинство событий в природе. Во время сильных ураганов и штормов ущерб, нанесенный растениям и домам, рассматривался как предзнаменование. Иногда поверх лежащих на земле листьев можно было увидеть какой-то странный мусор. Это был очень плохой знак, говорящий о том, что в скором времени на семью обрушится болезнь. Некоторые мистики также утверждали, что в шуме ветра слышат голоса, предсказывающие чью-то смерть.
В древней ирландской традиции для гадания использовали небо, звезды и ветер. Сегодня это называется хаомантией и охватывает большинство событий в природе. Во время сильных ураганов и штормов ущерб, нанесенный растениям и домам, рассматривался как предзнаменование. Иногда поверх лежащих на земле листьев можно было увидеть какой-то странный мусор. Это был очень плохой знак, говорящий о том, что в скором времени на семью обрушится болезнь. Некоторые мистики также утверждали, что в шуме ветра слышат голоса, предсказывающие чью-то смерть. В 1879 году во время экспедиции по Аризоне когда торговец Дон Магуайр (Don Maguire) переплывал реку Колорадо, он встретился с Эммой Ли (Emma Lee). В обмен на некоторые товары Магуайра, которые были нужны Ли, она дала ему красивое индейское покрывало, но предупредила дельца о том, что у этой вещи темное прошлое. По словам женщины проклятое одеяло принесло ее покойному мужу одни только беды. Магуайр не был суеверным человеком и покинул каньон на следующий же день, прихватив с собой и индейскую реликвию. В течение следующих 2 лет торговец вел личный дневник, в котором он записывал, как мучился из-за «сотни бедствий», прекратившихся сразу же после потери того самого злосчастного покрывала.
В 1879 году во время экспедиции по Аризоне когда торговец Дон Магуайр (Don Maguire) переплывал реку Колорадо, он встретился с Эммой Ли (Emma Lee). В обмен на некоторые товары Магуайра, которые были нужны Ли, она дала ему красивое индейское покрывало, но предупредила дельца о том, что у этой вещи темное прошлое. По словам женщины проклятое одеяло принесло ее покойному мужу одни только беды. Магуайр не был суеверным человеком и покинул каньон на следующий же день, прихватив с собой и индейскую реликвию. В течение следующих 2 лет торговец вел личный дневник, в котором он записывал, как мучился из-за «сотни бедствий», прекратившихся сразу же после потери того самого злосчастного покрывала. В Великом каньоне живет множество очень опасных животных, беспрепятственно снующих по просторам национального парка. Горные львы, бурые медведи и лоси – всего лишь некоторые из представителей диких зверей, обитающих в этих землях, и способных напасть на человека без малейшего предупреждения.
В Великом каньоне живет множество очень опасных животных, беспрепятственно снующих по просторам национального парка. Горные львы, бурые медведи и лоси – всего лишь некоторые из представителей диких зверей, обитающих в этих землях, и способных напасть на человека без малейшего предупреждения. За последние сто лет находки человеческих останков в Гранд-Каньоне стали довольно частым явлением. Такие ужасные открытия вполне объяснимы, учитывая сколько нераскрытых дел хранится в базе данных окружного шерифа из Коконино (Coconino). Попытки опознать обнаруженные останки и раскрыть дела о таинственных исчезновениях и трагических смертях привели к созданию специальной следственной группы, занимающейся именно такими холодными или нераскрытыми случаями, связанными с легендарным заповедником.
За последние сто лет находки человеческих останков в Гранд-Каньоне стали довольно частым явлением. Такие ужасные открытия вполне объяснимы, учитывая сколько нераскрытых дел хранится в базе данных окружного шерифа из Коконино (Coconino). Попытки опознать обнаруженные останки и раскрыть дела о таинственных исчезновениях и трагических смертях привели к созданию специальной следственной группы, занимающейся именно такими холодными или нераскрытыми случаями, связанными с легендарным заповедником. Большой каньон частенько становился местом, где совершались самые странные и нелепые самоубийства в истории Америки. Дело 36-летней Патрисии Астольфо (Patricia Astolfo) – хороший тому пример. После 50 просмотров фильма «Тельма и Луиза» (Thelma and Louisemore, американское кино в стиле роуд-муви) Патрисия села за руль и попыталась слететь на своей машине с края крутой скалы. Подвеска автомобиля зацепилась за каменистый выступ, и это разрушило первоначальные планы впечатлительной дамы. Упорная американка выбралась из машины и спрыгнула вниз, но вновь потерпела неудачу, упав всего на 6 метров, и приземлившись на громадный валун, выступающий из скалы. Окровавленная и вся в синяках, Патрисия Астольфо доползла до края выступа, перекатилась через него и «наконец-то» разбилась насмерть.
Большой каньон частенько становился местом, где совершались самые странные и нелепые самоубийства в истории Америки. Дело 36-летней Патрисии Астольфо (Patricia Astolfo) – хороший тому пример. После 50 просмотров фильма «Тельма и Луиза» (Thelma and Louisemore, американское кино в стиле роуд-муви) Патрисия села за руль и попыталась слететь на своей машине с края крутой скалы. Подвеска автомобиля зацепилась за каменистый выступ, и это разрушило первоначальные планы впечатлительной дамы. Упорная американка выбралась из машины и спрыгнула вниз, но вновь потерпела неудачу, упав всего на 6 метров, и приземлившись на громадный валун, выступающий из скалы. Окровавленная и вся в синяках, Патрисия Астольфо доползла до края выступа, перекатилась через него и «наконец-то» разбилась насмерть. Гостиница El Tovar Hotel находится всего в 6 метрах от смотровой площадки скалы Южный Рим, и она была настоящим воплощением люкса, когда только открылась в 1905 году. С тех пор здесь постоянно жаловались на призраков, и перепуганные постояльцы регулярно покидают отель с обещаниями никогда больше не возвращаться в это жуткое место с привидениями.
Гостиница El Tovar Hotel находится всего в 6 метрах от смотровой площадки скалы Южный Рим, и она была настоящим воплощением люкса, когда только открылась в 1905 году. С тех пор здесь постоянно жаловались на призраков, и перепуганные постояльцы регулярно покидают отель с обещаниями никогда больше не возвращаться в это жуткое место с привидениями. Во все времена жили люди, жаждущие приключений, и молодожены Глен и Бесси были из их числа. Зимой 1928 года они решили сплавиться по реке Большого каньона. Спустя месяц путешествия Хайдов их самодельная деревянная лодка была обнаружена перевернутой и заполненной холодной водой. За несколько дней до того пара была замечена в районе Южного Рима, где супруги пополняли свои запасы. Тогда же, как вспоминали свидетели, 22-летняя Бесси воскликнула: «Интересно, обую ли я еще когда-то свои красивые туфли».
Во все времена жили люди, жаждущие приключений, и молодожены Глен и Бесси были из их числа. Зимой 1928 года они решили сплавиться по реке Большого каньона. Спустя месяц путешествия Хайдов их самодельная деревянная лодка была обнаружена перевернутой и заполненной холодной водой. За несколько дней до того пара была замечена в районе Южного Рима, где супруги пополняли свои запасы. Тогда же, как вспоминали свидетели, 22-летняя Бесси воскликнула: «Интересно, обую ли я еще когда-то свои красивые туфли». В 1978 году Роберт Спэнглер застрелил собственную жену Нэнси и двух своих детишек прямо в их загородном доме в Денвере (Denver). Затем убийца попытался представить все так, будто детей убила Нэнси, и что потом она совершила самоубийство. Тест на следы пороха на руках Роберта оказался положительным, но следователям не удалось построить против вдовца полноценное дело, хотя его они подозревали с самого начала. Еще 15 лет мужчина гулял на свободе, пока он не оказался замешанным в трагическом событии вновь. В 1993 году во время отдыха в Гранд-Каньоне Роберт столкнул с края скалы свою третью жену Донну (Donna). Несчастная пролетела 60 метров и разбилась насмерть.
В 1978 году Роберт Спэнглер застрелил собственную жену Нэнси и двух своих детишек прямо в их загородном доме в Денвере (Denver). Затем убийца попытался представить все так, будто детей убила Нэнси, и что потом она совершила самоубийство. Тест на следы пороха на руках Роберта оказался положительным, но следователям не удалось построить против вдовца полноценное дело, хотя его они подозревали с самого начала. Еще 15 лет мужчина гулял на свободе, пока он не оказался замешанным в трагическом событии вновь. В 1993 году во время отдыха в Гранд-Каньоне Роберт столкнул с края скалы свою третью жену Донну (Donna). Несчастная пролетела 60 метров и разбилась насмерть. В 1869 году Джон Уэсли Пауэлл в компании с другими единомышленниками отправился на свой первый сплав по реке Колорадо, выбрав для экспедиции малоизвестный участок Великого каньона с очень сильным течением. Почти в самом конце сплава группа столкнулась с очень опасными порогами, преодолеть которые было практически невозможно. Убежденные в самоубийственности плана Пауэлла, намеревавшегося сплавляться дальше, трое мужчин покинуло однорукого ветерана Гражданской войны, и они отправились искать спасение на скалах каньона. Вопреки опасности Пауэлл и остальные члены мероприятия продолжили свой путь по стремительным потокам бурной реки. Два дня спустя группа чудом добралась до устья реки Вирджин (Virgin), где на берегу их встретили поселенцы. По иронии судьбы, три бунтаря, покинувшие экспедицию ранее из страха за свою жизнь, в итоге погибли. Где-то на пути из каньона эти мужчины попали в руки коренных индейцев, которые убили бледнолицых в отместку за нападение на женщину из их племени.
В 1869 году Джон Уэсли Пауэлл в компании с другими единомышленниками отправился на свой первый сплав по реке Колорадо, выбрав для экспедиции малоизвестный участок Великого каньона с очень сильным течением. Почти в самом конце сплава группа столкнулась с очень опасными порогами, преодолеть которые было практически невозможно. Убежденные в самоубийственности плана Пауэлла, намеревавшегося сплавляться дальше, трое мужчин покинуло однорукого ветерана Гражданской войны, и они отправились искать спасение на скалах каньона. Вопреки опасности Пауэлл и остальные члены мероприятия продолжили свой путь по стремительным потокам бурной реки. Два дня спустя группа чудом добралась до устья реки Вирджин (Virgin), где на берегу их встретили поселенцы. По иронии судьбы, три бунтаря, покинувшие экспедицию ранее из страха за свою жизнь, в итоге погибли. Где-то на пути из каньона эти мужчины попали в руки коренных индейцев, которые убили бледнолицых в отместку за нападение на женщину из их племени. Одна из самых смертельных авиакатастроф в истории Америки случилась утром 30 июня 1956 года. Где-то через час после вылета из международного аэропорта Лос-Анжелеса рейсы United Airlines 718 и TWA 2 столкнулись друг с другом в воздухе над Гранд-Каньоном. Спасательно-поисковые команды обнаружили обломки самолетов на следующий день, и Совет по гражданской авиации США начал незамедлительное расследование случившегося. Как оказалось, пилоты обоих рейсов сбились с назначенных маршрутов, и их самолеты летели одновременно на одной высоте. Из-за повышенной облачности пилоты увидели друг друга слишком поздно, и избежать столкновения на тот момент было уже невозможно.
Одна из самых смертельных авиакатастроф в истории Америки случилась утром 30 июня 1956 года. Где-то через час после вылета из международного аэропорта Лос-Анжелеса рейсы United Airlines 718 и TWA 2 столкнулись друг с другом в воздухе над Гранд-Каньоном. Спасательно-поисковые команды обнаружили обломки самолетов на следующий день, и Совет по гражданской авиации США начал незамедлительное расследование случившегося. Как оказалось, пилоты обоих рейсов сбились с назначенных маршрутов, и их самолеты летели одновременно на одной высоте. Из-за повышенной облачности пилоты увидели друг друга слишком поздно, и избежать столкновения на тот момент было уже невозможно. Среди всех самых трагических происшествий Большого каньона, включая самоубийства, нападения диких животных, падения со смотровых площадок, удары молнией и так далее, пожалуй, самыми жуткими остаются убийства ни в чем не повинных туристов.
Среди всех самых трагических происшествий Большого каньона, включая самоубийства, нападения диких животных, падения со смотровых площадок, удары молнией и так далее, пожалуй, самыми жуткими остаются убийства ни в чем не повинных туристов. Женщины ОЧЕНЬ хорошо знают, как управлять мужчинами.
Женщины ОЧЕНЬ хорошо знают, как управлять мужчинами. Хотя кажется, что это лишено смысла, но дефицит песка вполне реален. Песок используется нами ежедневно, потому что он является важным компонентом для бетона, стекла и асфальта. Песок – это не просто игра в пустыне. Это наши дороги, небоскребы и даже наша зубная паста.
Хотя кажется, что это лишено смысла, но дефицит песка вполне реален. Песок используется нами ежедневно, потому что он является важным компонентом для бетона, стекла и асфальта. Песок – это не просто игра в пустыне. Это наши дороги, небоскребы и даже наша зубная паста. Первые антибиотики для борьбы с этим ЗППП стали доступны еще в 1940-х годах, но, как и большинство бактерий, бактерия гонореи способна мутировать и становится только сильнее от тех пуль-таблеток, которыми мы в нее стреляем.
Первые антибиотики для борьбы с этим ЗППП стали доступны еще в 1940-х годах, но, как и большинство бактерий, бактерия гонореи способна мутировать и становится только сильнее от тех пуль-таблеток, которыми мы в нее стреляем. Скажем воздушным шарам, наполненным гелием: «До свидания», – запасы гелия на планете постепенно заканчиваются. Это очень печально, потому что он используется достаточно часто. Этот невозобновляемый ресурс применяют для охлаждения сверхпроводящих магнитов на машинах МРТ, а также для обнаружения утечки при испытании контейнеров, подвергаемых воздействию высокого давления. Многие ученые используют его для достижения сверх низких температур любого криогена, чтобы дать иметь возможность четко рассмотреть квантово-механические явления. Во многих ситуациях, где используется гелий, его нельзя заменить каким-либо другим элементом. Если мы не найдем лучшего способа рационально расходовать оставшиеся в нашем распоряжении запасы, то придется добывать гелий с Луны.
Скажем воздушным шарам, наполненным гелием: «До свидания», – запасы гелия на планете постепенно заканчиваются. Это очень печально, потому что он используется достаточно часто. Этот невозобновляемый ресурс применяют для охлаждения сверхпроводящих магнитов на машинах МРТ, а также для обнаружения утечки при испытании контейнеров, подвергаемых воздействию высокого давления. Многие ученые используют его для достижения сверх низких температур любого криогена, чтобы дать иметь возможность четко рассмотреть квантово-механические явления. Во многих ситуациях, где используется гелий, его нельзя заменить каким-либо другим элементом. Если мы не найдем лучшего способа рационально расходовать оставшиеся в нашем распоряжении запасы, то придется добывать гелий с Луны. В данном случае речь не идет о нехватке ингредиентов для производства таких препаратов. Проблема в том, что никто из производителей больше не хочет, чтобы его имя связывали с убийством. В 2016 году фармацевтический гигант Pfizer присоединился к 20 другим американским и европейским фармацевтическим компаниям и заблокировал применение таких препаратов для казни.
В данном случае речь не идет о нехватке ингредиентов для производства таких препаратов. Проблема в том, что никто из производителей больше не хочет, чтобы его имя связывали с убийством. В 2016 году фармацевтический гигант Pfizer присоединился к 20 другим американским и европейским фармацевтическим компаниям и заблокировал применение таких препаратов для казни. Основываясь на расчетах, ученые пришли к выводу, что верхнего слоя почвы нам хватит всего на 60 лет. Сельское хозяйство на одной и той же территории с тем же количеством высаживаемых растений приводит к тому, что все питательные вещества поглощаются из почвы, делая ее абсолютно бесполезной.
Основываясь на расчетах, ученые пришли к выводу, что верхнего слоя почвы нам хватит всего на 60 лет. Сельское хозяйство на одной и той же территории с тем же количеством высаживаемых растений приводит к тому, что все питательные вещества поглощаются из почвы, делая ее абсолютно бесполезной. Всестороннее исследование показало, что среди жителей Северной Америки, Европы, Австралии и Новой Зеландии с 1973 по 2011 год концентрация сперматозоидов в сперме снизились на 52,4 процента. Эти отклонения имеют большее значение для репродуктивного здоровья, а, кроме того, плохое состояние спермы приводит в дальнейшем к повышению общей заболеваемости и смертности.
Всестороннее исследование показало, что среди жителей Северной Америки, Европы, Австралии и Новой Зеландии с 1973 по 2011 год концентрация сперматозоидов в сперме снизились на 52,4 процента. Эти отклонения имеют большее значение для репродуктивного здоровья, а, кроме того, плохое состояние спермы приводит в дальнейшем к повышению общей заболеваемости и смертности. Это один из самых сложных случаев в нашем списке. В настоящее время речь идет о том, что, если мы будем продолжать вылавливать запасы рыбы с той скоростью, с которой сейчас это делаем, то будем близки к тому, чтобы опорожнить океан. Улов сокращается ежегодно на 2%, и самое страшное заключается в том, что крупные промысловые компании в значительной степени занижают цифры в отчетах для Продовольственной и Сельскохозяйственной Организации ООН (FAO).
Это один из самых сложных случаев в нашем списке. В настоящее время речь идет о том, что, если мы будем продолжать вылавливать запасы рыбы с той скоростью, с которой сейчас это делаем, то будем близки к тому, чтобы опорожнить океан. Улов сокращается ежегодно на 2%, и самое страшное заключается в том, что крупные промысловые компании в значительной степени занижают цифры в отчетах для Продовольственной и Сельскохозяйственной Организации ООН (FAO). К сожалению, эта проблема немного сложнее, чем просто необходимость удалить нескольких фотографий на телефоне, чтобы освободить место. Данные никогда еще не были столь важными, как сегодня. Они становятся жизненно необходимыми для ведения бизнеса во всем мире. По прогнозам, к 2020 году у нас будет задействовано 26 миллиардов связанных между собой устройств, и это не включая еще примерно 7 миллиардов смартфонов, ПК и планшетов.
К сожалению, эта проблема немного сложнее, чем просто необходимость удалить нескольких фотографий на телефоне, чтобы освободить место. Данные никогда еще не были столь важными, как сегодня. Они становятся жизненно необходимыми для ведения бизнеса во всем мире. По прогнозам, к 2020 году у нас будет задействовано 26 миллиардов связанных между собой устройств, и это не включая еще примерно 7 миллиардов смартфонов, ПК и планшетов. Горная промышленность может быстро развиваться, когда речь идет о добыче песка, но еще одно желтое вещество добывать намного труднее. За последнее десятилетие золотодобытчики смогли открыть лишь несколько месторождений. Многие горнодобывающие компании вынуждены были аннулировать свои проекты из-за чрезмерного риска. Расходы на добычу золота уменьшились с 10 млрд. долларов США в 2012 году до едва 4 млрд. долларов США в 2016 году. Ожидается, что в ближайшие три-четыре года поставки сократятся на 15-20 процентов.
Горная промышленность может быстро развиваться, когда речь идет о добыче песка, но еще одно желтое вещество добывать намного труднее. За последнее десятилетие золотодобытчики смогли открыть лишь несколько месторождений. Многие горнодобывающие компании вынуждены были аннулировать свои проекты из-за чрезмерного риска. Расходы на добычу золота уменьшились с 10 млрд. долларов США в 2012 году до едва 4 млрд. долларов США в 2016 году. Ожидается, что в ближайшие три-четыре года поставки сократятся на 15-20 процентов. В формировании этого дефицита участвуют множество факторов. Во-первых, число пожилых людей резко возрастает. С 2010 по 2030 год число пенсионеров только в США увеличится на 75 процентов, до 69 миллионов. Это означает, что каждый пятый человек будет в преклонном возрасте.
В формировании этого дефицита участвуют множество факторов. Во-первых, число пожилых людей резко возрастает. С 2010 по 2030 год число пенсионеров только в США увеличится на 75 процентов, до 69 миллионов. Это означает, что каждый пятый человек будет в преклонном возрасте. Гаптофобия – это страх прикосновений. Это звучит смешно, но такая фобия, действительно, существует, и ее жертвы испытывают из-за нее очень сильный дискомфорт. Для страдающих от гаптофобии любое прикосновение может стать не только большим эмоциональным стрессом, но и физически болезненным ощущением. В некоторых случаях фобия связана только с определенным полом человека, но бывает и так, что не важно, дотронулся ли до гаптофоба мужчина или женщина.
Гаптофобия – это страх прикосновений. Это звучит смешно, но такая фобия, действительно, существует, и ее жертвы испытывают из-за нее очень сильный дискомфорт. Для страдающих от гаптофобии любое прикосновение может стать не только большим эмоциональным стрессом, но и физически болезненным ощущением. В некоторых случаях фобия связана только с определенным полом человека, но бывает и так, что не важно, дотронулся ли до гаптофоба мужчина или женщина. Эргофобия – это страх перед работой. Невероятно, но в мире есть люди, которые реально страдают от такой фобии. Лорна Либенберг (Lorna Liebenberg) – яркий тому пример. На протяжении 17 лет Лорна тяжело трудилась, но теперь женщина больше не в состоянии вернуться к былому образу жизни. Когда она начинает думать о работе, ее сковывает всепоглощающий ужас. Случай Либенберг такой тяжелый, что всякий раз при попытке устроиться на новую работу ее страх только возрастает, и в итоге она абсолютно не способна задержаться на новом месте слишком надолго. Вопреки тому, что у нее бывали очень хорошие начальники, которые заботились о Лорне, как о дочери, она все равно не могла совладать с чрезвычайной тревогой, когда оказывалась в рабочей среде и в условиях трудовой дисциплины. Неудивительно, что со временем у женщины возникли серьезные и непрекращающиеся проблемы с деньгами.
Эргофобия – это страх перед работой. Невероятно, но в мире есть люди, которые реально страдают от такой фобии. Лорна Либенберг (Lorna Liebenberg) – яркий тому пример. На протяжении 17 лет Лорна тяжело трудилась, но теперь женщина больше не в состоянии вернуться к былому образу жизни. Когда она начинает думать о работе, ее сковывает всепоглощающий ужас. Случай Либенберг такой тяжелый, что всякий раз при попытке устроиться на новую работу ее страх только возрастает, и в итоге она абсолютно не способна задержаться на новом месте слишком надолго. Вопреки тому, что у нее бывали очень хорошие начальники, которые заботились о Лорне, как о дочери, она все равно не могла совладать с чрезвычайной тревогой, когда оказывалась в рабочей среде и в условиях трудовой дисциплины. Неудивительно, что со временем у женщины возникли серьезные и непрекращающиеся проблемы с деньгами. Неофобия – это боязнь всего нового, будь то непривычные ситуации, незнакомые места или вещи. Люди, страдающие от неофобии, обычно испытывают большие проблемы, сталкиваясь с новыми технологиями, незнакомыми кулинарными блюдами, модной одеждой и другими неотъемлемыми атрибутами развивающегося общества. Вопреки логичным преимуществам новых вещей, неофобы всеми силами сопротивляются появлению новшеств в их жизнях, что порой вызывает немало трудностей. Такую боязнь легко счесть незначительной, но на деле она очень негативно влияет на жизнь больного и его близких.
Неофобия – это боязнь всего нового, будь то непривычные ситуации, незнакомые места или вещи. Люди, страдающие от неофобии, обычно испытывают большие проблемы, сталкиваясь с новыми технологиями, незнакомыми кулинарными блюдами, модной одеждой и другими неотъемлемыми атрибутами развивающегося общества. Вопреки логичным преимуществам новых вещей, неофобы всеми силами сопротивляются появлению новшеств в их жизнях, что порой вызывает немало трудностей. Такую боязнь легко счесть незначительной, но на деле она очень негативно влияет на жизнь больного и его близких. Филофобия – это страх влюбиться и испытывать чувства симпатии и привязанности к другому человеку. Эта боязнь тесно связана с травмирующим опытом из прошлого, с несчастной любовью или сложными отношениями. Например, если в прошлом у вас был сложный развод, это может стать причиной возникновения филофобии.
Филофобия – это страх влюбиться и испытывать чувства симпатии и привязанности к другому человеку. Эта боязнь тесно связана с травмирующим опытом из прошлого, с несчастной любовью или сложными отношениями. Например, если в прошлом у вас был сложный развод, это может стать причиной возникновения филофобии. Аблутофобия – это страх купаться, мыться и принимать ванную. Эта довольно специфичная боязнь чаще всего присуща женщинам и детям, и намного реже – мужчинам. Фобия проявляется по-разному – от страха перед душем до боязни любого вида гигиенических процедур.
Аблутофобия – это страх купаться, мыться и принимать ванную. Эта довольно специфичная боязнь чаще всего присуща женщинам и детям, и намного реже – мужчинам. Фобия проявляется по-разному – от страха перед душем до боязни любого вида гигиенических процедур. Номофобия – это страх остаться без мобильного телефона. Причиной появления такого заболевания стала растущая зависимость современных людей от технологий. Известно, что причиной номофобии чаще всего становится неприятный жизненный опыт, связанный с отсутствием телефона в сложной или опасной ситуации.
Номофобия – это страх остаться без мобильного телефона. Причиной появления такого заболевания стала растущая зависимость современных людей от технологий. Известно, что причиной номофобии чаще всего становится неприятный жизненный опыт, связанный с отсутствием телефона в сложной или опасной ситуации. Некоторые фобии похожи на выдумки из голливудских комедий, и наша следующая по списку боязнь как раз такая. Децидофобия – это страх принятия решений. Люди, страдающие от этой боязни, обычно испытывают очень сильную тревогу, если им приходится вставать перед выбором, и наступает время принять какое-либо решение.
Некоторые фобии похожи на выдумки из голливудских комедий, и наша следующая по списку боязнь как раз такая. Децидофобия – это страх принятия решений. Люди, страдающие от этой боязни, обычно испытывают очень сильную тревогу, если им приходится вставать перед выбором, и наступает время принять какое-либо решение. Гелиофобия – это преувеличенный и иррациональный страх солнечного света. Чаще всего причиной такой боязни становится неправильно воспринятая информация. Например, если человек верит, что слишком долгое пребывание под солнцем может вызвать рак, в некоторых случаях он может стать гелиофобом. Еще один пример – солнечные ожоги. Если вы сильно сгорели на пляже, это может стать тем самым травмирующим опытом, который в дальнейшем будущем может вызвать очень серьезный страх появляться на улице в дневное время дня.
Гелиофобия – это преувеличенный и иррациональный страх солнечного света. Чаще всего причиной такой боязни становится неправильно воспринятая информация. Например, если человек верит, что слишком долгое пребывание под солнцем может вызвать рак, в некоторых случаях он может стать гелиофобом. Еще один пример – солнечные ожоги. Если вы сильно сгорели на пляже, это может стать тем самым травмирующим опытом, который в дальнейшем будущем может вызвать очень серьезный страх появляться на улице в дневное время дня. Генофобия – это иррациональный страх вступать в сексуальные отношения. Генофобы приходят в ужас от одной мысли о половом акте или обо всем с ним связанном. Этот страх возникает из-за травматических воспоминаний об изнасиловании или домогательстве. Жертва могла пережить болезненный опыт полового контакта или домогательств даже несколько раз, что в итоге и спровоцировало развитие генофобии. Вдобавок страх секса иногда возникает из-за переживаний по поводу навыков в этом деле, особенно в случаях, когда у больного очень мало опыта половой жизни, или же ее не было очень давно.
Генофобия – это иррациональный страх вступать в сексуальные отношения. Генофобы приходят в ужас от одной мысли о половом акте или обо всем с ним связанном. Этот страх возникает из-за травматических воспоминаний об изнасиловании или домогательстве. Жертва могла пережить болезненный опыт полового контакта или домогательств даже несколько раз, что в итоге и спровоцировало развитие генофобии. Вдобавок страх секса иногда возникает из-за переживаний по поводу навыков в этом деле, особенно в случаях, когда у больного очень мало опыта половой жизни, или же ее не было очень давно. Логофобия – это страх выступать перед многочисленной публикой. Жертвы глоссофобии не способны контролировать всепоглощающую тревогу, которая возникает всякий раз, когда такому человеку приходится говорить перед аудиторией из нескольких человек. Речь перед публикой грозит настоящим нервным срывом, и страдающие от этой фобии стараются всеми силами избегать обстоятельств, во время которых есть опасность оказаться в центре внимания большого количества людей.
Логофобия – это страх выступать перед многочисленной публикой. Жертвы глоссофобии не способны контролировать всепоглощающую тревогу, которая возникает всякий раз, когда такому человеку приходится говорить перед аудиторией из нескольких человек. Речь перед публикой грозит настоящим нервным срывом, и страдающие от этой фобии стараются всеми силами избегать обстоятельств, во время которых есть опасность оказаться в центре внимания большого количества людей.









 1. Морган Робертсон предсказал крушение «Титаника»
1. Морган Робертсон предсказал крушение «Титаника» Смерть неизбежна на нашем пути. Тем не менее, некоторые люди умирали настолько странным способом, что благодаря этому они вошли в историю. Далее представлены восемь историй о самых нелепых смертях в истории человечества.
Смерть неизбежна на нашем пути. Тем не менее, некоторые люди умирали настолько странным способом, что благодаря этому они вошли в историю. Далее представлены восемь историй о самых нелепых смертях в истории человечества. Coca-Cola является едва ли не самым узнаваемым брендом на земле. Заводы по производству этого замечательного напитка существуют практические в каждой стране. Но, несмотря на общую признанность Coca-Cola, мало кто имеет представление о том, чем на самом деле является данный лимонад. Далее вы узнаете шесть необычных фактов о Coca-Cola, которые расширят ваш кругозор.
Coca-Cola является едва ли не самым узнаваемым брендом на земле. Заводы по производству этого замечательного напитка существуют практические в каждой стране. Но, несмотря на общую признанность Coca-Cola, мало кто имеет представление о том, чем на самом деле является данный лимонад. Далее вы узнаете шесть необычных фактов о Coca-Cola, которые расширят ваш кругозор. Вопрос о происхождении домашних кур не вызывает у ученых дискуссий. То, что они произошли от диких банкивских кур (Gallus bankiva) не подвергается сомнениям. Не спорят биологи и о других предках этого животного – таких, как серая джунглевая курица, цейлонская джунглевая курица и зелёная джунглевая курица. Более того, успехи генетиков позволяют оценить время одомашнивания этой птицы. Анализ показывает, что митохондриальная курица, являющаяся общим предком всего куриного поголовья, появилась около 3500 лет до нашей эры в Азии. В принципе это не противоречит другим попыткам одомашнивания в более древнее время, о которых пишет исследователь Докинз Ричард.
Вопрос о происхождении домашних кур не вызывает у ученых дискуссий. То, что они произошли от диких банкивских кур (Gallus bankiva) не подвергается сомнениям. Не спорят биологи и о других предках этого животного – таких, как серая джунглевая курица, цейлонская джунглевая курица и зелёная джунглевая курица. Более того, успехи генетиков позволяют оценить время одомашнивания этой птицы. Анализ показывает, что митохондриальная курица, являющаяся общим предком всего куриного поголовья, появилась около 3500 лет до нашей эры в Азии. В принципе это не противоречит другим попыткам одомашнивания в более древнее время, о которых пишет исследователь Докинз Ричард. Мозг человека — по факту самая загадочная система познания мира с творческими и удивительными способностями.
Мозг человека — по факту самая загадочная система познания мира с творческими и удивительными способностями.
 В ноябре 1885 года Гильермо Фарини (Guillermo Farini), канадский эквилибрист, изобретатель и авантюрист, написал отчет о странном и загадочном городе, который повстречался ему во время нашумевшего путешествия через африканскую пустыню Калахари. Свой труд он представил на суд Берлинскому географическому обществу, а в 1886 году обратился уже и в Королевское географическое общество Великобритании. В тот же год Фарини даже напечатал собственную книгу, в которой он детально описал свое открытие. В своем издании путешественник рассказал про таинственные образования из горной породы, которые по убеждению автора были руинами древнего города. Канадец утверждал, что город был построен в форме огромной арки, и некоторые его части были зарыты глубоко в песок. На месте Фарини не нашел никаких надписей или отличительных символов, поэтому он решил, что этому городу должно быть несколько тысяч лет.
В ноябре 1885 года Гильермо Фарини (Guillermo Farini), канадский эквилибрист, изобретатель и авантюрист, написал отчет о странном и загадочном городе, который повстречался ему во время нашумевшего путешествия через африканскую пустыню Калахари. Свой труд он представил на суд Берлинскому географическому обществу, а в 1886 году обратился уже и в Королевское географическое общество Великобритании. В тот же год Фарини даже напечатал собственную книгу, в которой он детально описал свое открытие. В своем издании путешественник рассказал про таинственные образования из горной породы, которые по убеждению автора были руинами древнего города. Канадец утверждал, что город был построен в форме огромной арки, и некоторые его части были зарыты глубоко в песок. На месте Фарини не нашел никаких надписей или отличительных символов, поэтому он решил, что этому городу должно быть несколько тысяч лет. В конце 1870-х годов главный архитектор часовни Лоретто в американском городе Санта Фе, Нью-Мексико (Santa Fe, New Mexico) внезапно скончался, так и не завершив свою работу над церковью, хотя на тот момент большая ее часть уже была построена. Тогда же рабочие и узнали, что их руководитель не предусмотрел внутри часовни лестницу для хорового балкона. Из-за скромных размеров храма обычная лестница там бы просто не поместилась, и плотники не могли придумать, как же им справиться с возникшей трудностью.
В конце 1870-х годов главный архитектор часовни Лоретто в американском городе Санта Фе, Нью-Мексико (Santa Fe, New Mexico) внезапно скончался, так и не завершив свою работу над церковью, хотя на тот момент большая ее часть уже была построена. Тогда же рабочие и узнали, что их руководитель не предусмотрел внутри часовни лестницу для хорового балкона. Из-за скромных размеров храма обычная лестница там бы просто не поместилась, и плотники не могли придумать, как же им справиться с возникшей трудностью. Неподалеку от курортного городка Поморие посреди виноградных и фруктовых садов скрывается рукотворная загадка. Прозванная гробницей Помория, эта конструкция представляет собой полуцилиндрический свод с центральной полой колонной, которая становится шире в своей верхней части под потолком. По оценкам экспертов, гробница была построена в промежутке между 2 и 4 веком нашей эры. Здесь также нашли следы винтовой лестницы, находившейся когда-то внутри колонны. Усыпальница была реконструирована в конце 1950-х годов.
Неподалеку от курортного городка Поморие посреди виноградных и фруктовых садов скрывается рукотворная загадка. Прозванная гробницей Помория, эта конструкция представляет собой полуцилиндрический свод с центральной полой колонной, которая становится шире в своей верхней части под потолком. По оценкам экспертов, гробница была построена в промежутке между 2 и 4 веком нашей эры. Здесь также нашли следы винтовой лестницы, находившейся когда-то внутри колонны. Усыпальница была реконструирована в конце 1950-х годов. В 1968 году в Чикаго мастер работал по заказу в частной квартире, которую давно пора было обновить. То, что сантехник обнаружил в старых стенах, было совершенно неожиданным! Разбирая кирпичную кладку, рабочий к своему изумлению столкнулся с замурованным там мотоциклом с надписью Трауб. Конечно же, всем захотелось найти первого хозяина старого здания, чтобы выяснить, как и зачем в квартире очутился этот необычный мотоцикл. Владельцы дома заявили, что их сын украл этот мотоцикл еще до своего отъезда на фронт в годы Первой мировой войны. Они также добавили, что именно сын спрятал такую необычную добычу в стене дома, но во время войны он погиб, и поэтому мотоцикл почти полвека пробыл в заточении, пока его не обнаружил сантехник.
В 1968 году в Чикаго мастер работал по заказу в частной квартире, которую давно пора было обновить. То, что сантехник обнаружил в старых стенах, было совершенно неожиданным! Разбирая кирпичную кладку, рабочий к своему изумлению столкнулся с замурованным там мотоциклом с надписью Трауб. Конечно же, всем захотелось найти первого хозяина старого здания, чтобы выяснить, как и зачем в квартире очутился этот необычный мотоцикл. Владельцы дома заявили, что их сын украл этот мотоцикл еще до своего отъезда на фронт в годы Первой мировой войны. Они также добавили, что именно сын спрятал такую необычную добычу в стене дома, но во время войны он погиб, и поэтому мотоцикл почти полвека пробыл в заточении, пока его не обнаружил сантехник. Окруженный Андскими горами, колумбийский городок под названием Са-Бернардо известен в первую очередь своей мистической тайной. Как и многие другие удаленные поселения на нашей планете, это место хранит свою особенную загадку, которую ученым еще только предстоит объяснить.
Окруженный Андскими горами, колумбийский городок под названием Са-Бернардо известен в первую очередь своей мистической тайной. Как и многие другие удаленные поселения на нашей планете, это место хранит свою особенную загадку, которую ученым еще только предстоит объяснить. Почти 150 лет тому назад исследователи начали поиски утерянных гробниц Маккавеев. В группу искателей вошли ученые, эксперты, путешественники и прочие заинтересованные лица. Однако успехом эта инициатива так и не увенчалась, хотя затею эту пока не бросают. В 2015 году археологическая находка в местечке Горбат-Ха-Гарди рядом с древним городом Модиин (Horbat Ha-Gardi, Modi’in) дала историкам надежду на то, что они наконец-то нашли вожделенные гробницы, но в итоге это оказался очередной тупик.
Почти 150 лет тому назад исследователи начали поиски утерянных гробниц Маккавеев. В группу искателей вошли ученые, эксперты, путешественники и прочие заинтересованные лица. Однако успехом эта инициатива так и не увенчалась, хотя затею эту пока не бросают. В 2015 году археологическая находка в местечке Горбат-Ха-Гарди рядом с древним городом Модиин (Horbat Ha-Gardi, Modi’in) дала историкам надежду на то, что они наконец-то нашли вожделенные гробницы, но в итоге это оказался очередной тупик. В конце 2014 года сотрудники национального парка Грейт-Бейсин в Неваде (Great Basin National Park, Nevada) занимались своими будничными делами, когда внезапно обнаружили нечто необычное. Прямо посреди леса к стволу можжевельника был прислонен винчестер. Даже беглого взгляда хватало, чтобы понять, что это была очень старая винтовка, но кто бы мог подумать, что ей окажется целых 130 лет.
В конце 2014 года сотрудники национального парка Грейт-Бейсин в Неваде (Great Basin National Park, Nevada) занимались своими будничными делами, когда внезапно обнаружили нечто необычное. Прямо посреди леса к стволу можжевельника был прислонен винчестер. Даже беглого взгляда хватало, чтобы понять, что это была очень старая винтовка, но кто бы мог подумать, что ей окажется целых 130 лет. Вплоть до 1961 года о манускрипте из архива румынского города Сибиу почти никто и ничего не слышал. Книга состоит из 450 страниц и датируется 16 веком. Однако удивил ученых именно текст этого рукописного труда. В книге описывается деятельность по созданию оружия, технические детали строительства многоступенчатых ракет и композиция жидкого топлива.
Вплоть до 1961 года о манускрипте из архива румынского города Сибиу почти никто и ничего не слышал. Книга состоит из 450 страниц и датируется 16 веком. Однако удивил ученых именно текст этого рукописного труда. В книге описывается деятельность по созданию оружия, технические детали строительства многоступенчатых ракет и композиция жидкого топлива. Легенды о смерти великого Чингисхана начали появляться буквально с момента его последнего вздоха в 1227 году. Основатель и первый хан Монгольской империи умер в возрасте 65 лет, но по слухам вопреки солидному возрасту почти до самой своей смерти он был очень бодр духом и телом. Кто-то говорил, что умер великий монгольский предводитель после падения с лошади во время сражения с китайцами. Другие считали, что хан заболел пневмонией или вовсе потерял слишком много крови после процедуры кастрации, что и свело его в могилу.
Легенды о смерти великого Чингисхана начали появляться буквально с момента его последнего вздоха в 1227 году. Основатель и первый хан Монгольской империи умер в возрасте 65 лет, но по слухам вопреки солидному возрасту почти до самой своей смерти он был очень бодр духом и телом. Кто-то говорил, что умер великий монгольский предводитель после падения с лошади во время сражения с китайцами. Другие считали, что хан заболел пневмонией или вовсе потерял слишком много крови после процедуры кастрации, что и свело его в могилу. В 1994 году на юге Мексики в одном из храмов посреди руин древнего города майя Паленке (Palenque) археолог Арнольдо Гонсалес Круз (Arnoldo Gonzales Cruz) со своей командой обнаружил загадочную усыпальницу. Внутри этой погребальной залы исследователи нашли гробницу с нетронутым саркофагом, по бокам которого лежало 2 скелета. Один из них принадлежал юному мальчику, а другой – женщине лет 30-40. Предположительно этих людей принесли в жертву другой женщине, сокрытой внутри самого саркофага. Вероятно, согласно верованиям древнего народа они должны были стать компаньонами усопшей в ее загробной жизни.
В 1994 году на юге Мексики в одном из храмов посреди руин древнего города майя Паленке (Palenque) археолог Арнольдо Гонсалес Круз (Arnoldo Gonzales Cruz) со своей командой обнаружил загадочную усыпальницу. Внутри этой погребальной залы исследователи нашли гробницу с нетронутым саркофагом, по бокам которого лежало 2 скелета. Один из них принадлежал юному мальчику, а другой – женщине лет 30-40. Предположительно этих людей принесли в жертву другой женщине, сокрытой внутри самого саркофага. Вероятно, согласно верованиям древнего народа они должны были стать компаньонами усопшей в ее загробной жизни.


















 Двадцать девятого октября 1969 года в девять вечера специалисты из Калифорнийского Университета, который расположен в Лос-Анджелесе в Калифорнии, а также научные сотрудники из Стэндфордского исследовательского института смогли провести первый сеанс связи на расстоянии в 640 километров. Стоит отметить, что именно эта дата и считается «Днем рождения» сети Интернет.
Двадцать девятого октября 1969 года в девять вечера специалисты из Калифорнийского Университета, который расположен в Лос-Анджелесе в Калифорнии, а также научные сотрудники из Стэндфордского исследовательского института смогли провести первый сеанс связи на расстоянии в 640 километров. Стоит отметить, что именно эта дата и считается «Днем рождения» сети Интернет. Энтомолог Роберт Данн из Университета штата Северная Каролина в городе Роли утверждает, что «наибольшее число видов живого мира, вымерших в прошлом, и находящихся на грани исчезновения сегодня, являются насекомыми». Хотя известно более миллиона представителей этого класса, эксперты сходятся во мнении, что существует огромное количество еще неоткрытых насекомых и эмпирически выводят цифры: сейчас на Земле сейчас обитает примерно 10 квинтиллионов насекомых.
Энтомолог Роберт Данн из Университета штата Северная Каролина в городе Роли утверждает, что «наибольшее число видов живого мира, вымерших в прошлом, и находящихся на грани исчезновения сегодня, являются насекомыми». Хотя известно более миллиона представителей этого класса, эксперты сходятся во мнении, что существует огромное количество еще неоткрытых насекомых и эмпирически выводят цифры: сейчас на Земле сейчас обитает примерно 10 квинтиллионов насекомых.
 И это не фантастика: подобная картина наблюдалась на пастбищах в Австралии в середине ХХ века, когда в силу непонятных причин там пропали жуки навозники.
И это не фантастика: подобная картина наблюдалась на пастбищах в Австралии в середине ХХ века, когда в силу непонятных причин там пропали жуки навозники. 1. Мужчины видят цвета иначе, чем женщины. Из-за двух Х-хромосом палитра цветов, которые видят женщины, шире. Поэтому женщины в разговоре оперируют оттенками цветов, мужчины говорят о фундаментальных.
1. Мужчины видят цвета иначе, чем женщины. Из-за двух Х-хромосом палитра цветов, которые видят женщины, шире. Поэтому женщины в разговоре оперируют оттенками цветов, мужчины говорят о фундаментальных.






 Любой кофеман подтвердит, что в первой утренней чашечке кофе есть своя истинная магия, которая помогает обрести баланс и поверить в то, что впереди вас ждет светлый день. Вы можете сказать, что это всего лишь самовнушение, и ничего более, но на самом деле у эмоционального подъема от кофе есть свое научное обоснование.
Любой кофеман подтвердит, что в первой утренней чашечке кофе есть своя истинная магия, которая помогает обрести баланс и поверить в то, что впереди вас ждет светлый день. Вы можете сказать, что это всего лишь самовнушение, и ничего более, но на самом деле у эмоционального подъема от кофе есть свое научное обоснование. Влияние кофе на наш мозг не заканчивается на хорошем настроении. Кофе творит чудеса и с нашей долгосрочной памятью. Исследования показали, что загрузка кофеином перед решением сложных задач может помочь в обработке информации и ее запоминании. Кофе помогает сфокусироваться на мыслительных процессах и улучшает реакцию.
Влияние кофе на наш мозг не заканчивается на хорошем настроении. Кофе творит чудеса и с нашей долгосрочной памятью. Исследования показали, что загрузка кофеином перед решением сложных задач может помочь в обработке информации и ее запоминании. Кофе помогает сфокусироваться на мыслительных процессах и улучшает реакцию. Любители кофе могут порадоваться, что их пристрастие заодно помогает им избегать еще и диабета. Да-да, вкусная чашечка кофейного напитка подстраховывает ваш инсулин, стимулируя выработку адипонектина – одного из веществ, участвующих в регуляции уровня сахара и инсулина в крови. Добавьте к этому антиоксиданты и магний, и ваш любимый напиток сразу же повышается в звании от вкуснейшего угощения до настоящего борца с опаснейшими болезнями. Это просто великолепно! Эффект, конечно же, носит временный характер и не гарантирует 100% защиту от всех бед, но кофе определенно точно вносит свой вклад и повышает качество жизни.
Любители кофе могут порадоваться, что их пристрастие заодно помогает им избегать еще и диабета. Да-да, вкусная чашечка кофейного напитка подстраховывает ваш инсулин, стимулируя выработку адипонектина – одного из веществ, участвующих в регуляции уровня сахара и инсулина в крови. Добавьте к этому антиоксиданты и магний, и ваш любимый напиток сразу же повышается в звании от вкуснейшего угощения до настоящего борца с опаснейшими болезнями. Это просто великолепно! Эффект, конечно же, носит временный характер и не гарантирует 100% защиту от всех бед, но кофе определенно точно вносит свой вклад и повышает качество жизни. Долгое время считалось, что кофе вреден для сердца, но недавние исследования опровергли это заблуждение. Оказывается, что между сердечно-сосудистыми заболеваниями и любовью к кофе нет никакой пагубной связи. Напротив, результаты наблюдений доказали, что кофе очень полезен для сердца. Кофе проявил себя преданным союзником нашего здоровья и помощником системы кровообращения. Умеренное употребление кофе не сильно, но все же снижает риск возникновения сердечного приступа. Благоприятное влияние кофе заметнее всего у женщин.
Долгое время считалось, что кофе вреден для сердца, но недавние исследования опровергли это заблуждение. Оказывается, что между сердечно-сосудистыми заболеваниями и любовью к кофе нет никакой пагубной связи. Напротив, результаты наблюдений доказали, что кофе очень полезен для сердца. Кофе проявил себя преданным союзником нашего здоровья и помощником системы кровообращения. Умеренное употребление кофе не сильно, но все же снижает риск возникновения сердечного приступа. Благоприятное влияние кофе заметнее всего у женщин. Если в конце трудного рабочего дня вы любите прийти домой и пропустить несколько бутылочек пива, то у нас есть хорошие новости и для вас. Регулярное употребление кофе может помочь вам в спасении печени, которую вы думали, что пропили еще в университете.
Если в конце трудного рабочего дня вы любите прийти домой и пропустить несколько бутылочек пива, то у нас есть хорошие новости и для вас. Регулярное употребление кофе может помочь вам в спасении печени, которую вы думали, что пропили еще в университете. Вы любите морковку? Это хорошо! Но оказывается, что любовь к кофе тоже может сыграть немаловажную роль для здоровья ваших глаз. Ученые обнаружили, что кофе очень полезен для человеческого зрения. Этот вкуснейший напиток содержит в себе хлорогеновую кислоту – мощнейший антиоксидант, доказавший свою способность бороться с ухудшением зрения из-за повреждения сетчатки. Кто знает, может, однажды появятся даже капли для глаз из хлорогеновой кислоты…
Вы любите морковку? Это хорошо! Но оказывается, что любовь к кофе тоже может сыграть немаловажную роль для здоровья ваших глаз. Ученые обнаружили, что кофе очень полезен для человеческого зрения. Этот вкуснейший напиток содержит в себе хлорогеновую кислоту – мощнейший антиоксидант, доказавший свою способность бороться с ухудшением зрения из-за повреждения сетчатки. Кто знает, может, однажды появятся даже капли для глаз из хлорогеновой кислоты… Недавние исследования доказали, что кофейные антиоксиданты снижают риск заболевания сразу несколькими видами рака. Оказывается, чем больше вы пьете кофе, тем более защищенным вы становитесь. Это значит, что выпивая в день от 4 чашек и более, вы практически уберегаете себя от злокачественных опухолей и спасаете свою жизнь! Польза кофе отмечена в случае таких видов опухолей, как рак полости рта, рак матки, рак простаты и рак головного мозга. И это только часть списка!
Недавние исследования доказали, что кофейные антиоксиданты снижают риск заболевания сразу несколькими видами рака. Оказывается, чем больше вы пьете кофе, тем более защищенным вы становитесь. Это значит, что выпивая в день от 4 чашек и более, вы практически уберегаете себя от злокачественных опухолей и спасаете свою жизнь! Польза кофе отмечена в случае таких видов опухолей, как рак полости рта, рак матки, рак простаты и рак головного мозга. И это только часть списка! Конечно же, большая чашка латте со сливками, сладким сиропом и шоколадной стружкой никак не поможет вам похудеть и даже наоборот навредит. Но если вы любите простой черный кофе, в вашем случае дела обстоят совсем иначе. Оказывается, что кофе на короткий срок помогает затормозить набор массы.
Конечно же, большая чашка латте со сливками, сладким сиропом и шоколадной стружкой никак не поможет вам похудеть и даже наоборот навредит. Но если вы любите простой черный кофе, в вашем случае дела обстоят совсем иначе. Оказывается, что кофе на короткий срок помогает затормозить набор массы. Многие сочтут этот пункт самым веселым и приятным – кофе помогает в постели! Вы готовы к подробностям? В случае женщин кофе способствует притоку крови к гениталиям, что означает повышенную возбудимость. Это отличная новость, разве нет? Выходит, что чашечка кофе за 15-30 минут до полового акта не только зарядит вас энергией, но и поспособствует повышенной возбудимости. Такое преимущество кофейного напитка заметно даже в случае тех, кто пьет его не чаще 1 раза в неделю.
Многие сочтут этот пункт самым веселым и приятным – кофе помогает в постели! Вы готовы к подробностям? В случае женщин кофе способствует притоку крови к гениталиям, что означает повышенную возбудимость. Это отличная новость, разве нет? Выходит, что чашечка кофе за 15-30 минут до полового акта не только зарядит вас энергией, но и поспособствует повышенной возбудимости. Такое преимущество кофейного напитка заметно даже в случае тех, кто пьет его не чаще 1 раза в неделю. Звучит невероятно, но кофе, действительно, может предотвратить смерть! Правда, ненадолго. Конечно же, ваш любимый утренний напиток нельзя назвать эликсиром вечной молодости или бессмертия, но он почти что близок к этим титулам… Доцент Стэндфордского университета (Stanford University), доктор наук Дэвид Фурман (David Furman), заявил следующее: «Свыше 90% всех неинфекционных заболеваний, сопутствующих старению, связаны с хроническими воспалениями». Но при чем тут кофе и бессмертие, спросите вы? Оказывается, что умеренное употребление кофе влияет на снижение активности генных кластеров, связанных с провоспалительным интерлейкином 1, бета (ген IL1B). Это длинная и сложная тема. Если в двух словах, то воспалительные процессы – это плохо, а кофе борется с воспалениями.
Звучит невероятно, но кофе, действительно, может предотвратить смерть! Правда, ненадолго. Конечно же, ваш любимый утренний напиток нельзя назвать эликсиром вечной молодости или бессмертия, но он почти что близок к этим титулам… Доцент Стэндфордского университета (Stanford University), доктор наук Дэвид Фурман (David Furman), заявил следующее: «Свыше 90% всех неинфекционных заболеваний, сопутствующих старению, связаны с хроническими воспалениями». Но при чем тут кофе и бессмертие, спросите вы? Оказывается, что умеренное употребление кофе влияет на снижение активности генных кластеров, связанных с провоспалительным интерлейкином 1, бета (ген IL1B). Это длинная и сложная тема. Если в двух словах, то воспалительные процессы – это плохо, а кофе борется с воспалениями.






 Ручной труд – это то, чем и теперь вы можете заниматься. Да, у нас есть генетические обусловленные данные, чтобы носить тяжелые грузы, и именно поэтому некоторые из нас любят ходить в спортзал. Однако ручной труд был тем, чем все мы вынуждены были заниматься в прошлом. Древним людям приходилось переносить тяжелые грузы, лазать по деревьям и горам и пробегать километры. Те, кто мог это делать, смогли выжить. Вот почему у наших предков были большие кости, и они были сильнее современного человека.
Ручной труд – это то, чем и теперь вы можете заниматься. Да, у нас есть генетические обусловленные данные, чтобы носить тяжелые грузы, и именно поэтому некоторые из нас любят ходить в спортзал. Однако ручной труд был тем, чем все мы вынуждены были заниматься в прошлом. Древним людям приходилось переносить тяжелые грузы, лазать по деревьям и горам и пробегать километры. Те, кто мог это делать, смогли выжить. Вот почему у наших предков были большие кости, и они были сильнее современного человека. Согласно данным современной науки, все люди мигрировали из Африки и Экватора 60 000 лет назад. Позже развились вариации, касающиеся тона кожи, текстуры волос и черт лица.
Согласно данным современной науки, все люди мигрировали из Африки и Экватора 60 000 лет назад. Позже развились вариации, касающиеся тона кожи, текстуры волос и черт лица. Самое древние цветные изображения были найдены в одной из пещер, и им 250 000 лет. Эта пещера находится в Замбии.
Самое древние цветные изображения были найдены в одной из пещер, и им 250 000 лет. Эта пещера находится в Замбии. Около 10 000-7 000 лет назад у большинства людей в мире были карие глаза. Никто не знает, почему, но определенные генетические мутации вызвали появление голубых глаз. Только у 8% населения голубые глаза.
Около 10 000-7 000 лет назад у большинства людей в мире были карие глаза. Никто не знает, почему, но определенные генетические мутации вызвали появление голубых глаз. Только у 8% населения голубые глаза. Давным-давно наши предки двигали ушами в направлении звука. Однако со временем эта способность стала ненужной для нас. Вот почему только 15% людей сейчас могут двигать этой мышцей сегодня.
Давным-давно наши предки двигали ушами в направлении звука. Однако со временем эта способность стала ненужной для нас. Вот почему только 15% людей сейчас могут двигать этой мышцей сегодня. Это то, что мы унаследовали от наших древних предков. Все они использовали это движение мышц, чтобы обнажить зубы. Такое поведение можно увидеть у собак и шимпанзе. Мы делаем так, когда злимся.
Это то, что мы унаследовали от наших древних предков. Все они использовали это движение мышц, чтобы обнажить зубы. Такое поведение можно увидеть у собак и шимпанзе. Мы делаем так, когда злимся. Homo sapiens был не единственным человеческим видом, который жил на этой планете. В одно время Homo Sapiens разделял ее, по крайней мере, еще двумя человеческими видами, но сейчас мы остаемся единственными. Вот почему мы все выглядим по-разному.
Homo sapiens был не единственным человеческим видом, который жил на этой планете. В одно время Homo Sapiens разделял ее, по крайней мере, еще двумя человеческими видами, но сейчас мы остаемся единственными. Вот почему мы все выглядим по-разному. Большая челюсть означает больше тестостерона. Вот почему мужчины любят женщин с маленькой челюстью, что означает больше эстрогенов.
Большая челюсть означает больше тестостерона. Вот почему мужчины любят женщин с маленькой челюстью, что означает больше эстрогенов. Неандертальцы жили вместе с нами примерно 25 000 лет назад. Никто не знает, что с ними случилось, но наука пытается разобраться в этом. Например, мы полагали, что только у людей была культура. Однако недавние исследования показывают, что неандертальцы хоронили своих мертвецов с цветами, что означает, что у них была религия, а следовательно – культура.
Неандертальцы жили вместе с нами примерно 25 000 лет назад. Никто не знает, что с ними случилось, но наука пытается разобраться в этом. Например, мы полагали, что только у людей была культура. Однако недавние исследования показывают, что неандертальцы хоронили своих мертвецов с цветами, что означает, что у них была религия, а следовательно – культура. Ученые выяснили, что у некоторых людей есть ДНК неандертальцев. Это означает, что люди и неандертальцы смешались.
Ученые выяснили, что у некоторых людей есть ДНК неандертальцев. Это означает, что люди и неандертальцы смешались. Люди любят исследовать, и часть их исследований должна была затронуть водоемы. Вот почему они построили лодки и начали плавать более 50 000 лет назад. Мы можем только догадываться, насколько примитивными были их лодки, но, если они могли плыть по Индийскому океану в Австралию, то были достаточно хороши.
Люди любят исследовать, и часть их исследований должна была затронуть водоемы. Вот почему они построили лодки и начали плавать более 50 000 лет назад. Мы можем только догадываться, насколько примитивными были их лодки, но, если они могли плыть по Индийскому океану в Австралию, то были достаточно хороши. Знаете ли вы, что люди – единственные животные, способные краснеть? Это интересная способность, которую мы развили благодаря нашей эволюции, и она заслуживает упоминания.
Знаете ли вы, что люди – единственные животные, способные краснеть? Это интересная способность, которую мы развили благодаря нашей эволюции, и она заслуживает упоминания. Испугайте ребенка, и он мигом вскарабкается куда-нибудь наверх. Эту привычку мы унаследовали от наших предков. Когда им угрожала опасность, они залазили на деревья.
Испугайте ребенка, и он мигом вскарабкается куда-нибудь наверх. Эту привычку мы унаследовали от наших предков. Когда им угрожала опасность, они залазили на деревья. Треть американцев отвергает Теорию эволюции.
Треть американцев отвергает Теорию эволюции. ДНК человека на 50% аналогична ДНК банана. Это означает, что мы бананолюди … Шутки в сторону, человеческая ДНК включает в себя более 60% ДНК цыплят и 80% ДНК коровы.
ДНК человека на 50% аналогична ДНК банана. Это означает, что мы бананолюди … Шутки в сторону, человеческая ДНК включает в себя более 60% ДНК цыплят и 80% ДНК коровы. Генетически мы более волосаты, чем другие приматы. Однако наши волосы легче, тоньше и короче.
Генетически мы более волосаты, чем другие приматы. Однако наши волосы легче, тоньше и короче. Ученые обнаружили, что бабушки всегда хорошо относились к своим внукам и всегда заботились о них. Это позволило матерям иметь больше детей, тем самым способствуя эволюции человечества.
Ученые обнаружили, что бабушки всегда хорошо относились к своим внукам и всегда заботились о них. Это позволило матерям иметь больше детей, тем самым способствуя эволюции человечества. Эта способность позволила нам стать лучшими охотниками на планете. Добавьте к этому превосходный мозг, и у вас есть одна из главных причин, по которой мы стали самыми опасными хищниками в дикой природе.
Эта способность позволила нам стать лучшими охотниками на планете. Добавьте к этому превосходный мозг, и у вас есть одна из главных причин, по которой мы стали самыми опасными хищниками в дикой природе. Люди любят симметрию. Вот почему они даже своих партнеров выбирают, ориентируясь на симметричность лица.
Люди любят симметрию. Вот почему они даже своих партнеров выбирают, ориентируясь на симметричность лица. Homo Sapiens существует около 200 000 лет. Мы превратились в главного хищника и стали самым умным животным. Однако мы недостаточно умны, чтобы уважать природу, которая дала нам жизнь. Будьте умнее, люди. Прекратите уничтожать эту прекрасную планету из-за таких эгоистических мотивов, как деньги. Найдите способ так эволюционировать, чтобы мы смогли наслаждаться этой планетой еще 200 000 лет.
Homo Sapiens существует около 200 000 лет. Мы превратились в главного хищника и стали самым умным животным. Однако мы недостаточно умны, чтобы уважать природу, которая дала нам жизнь. Будьте умнее, люди. Прекратите уничтожать эту прекрасную планету из-за таких эгоистических мотивов, как деньги. Найдите способ так эволюционировать, чтобы мы смогли наслаждаться этой планетой еще 200 000 лет. Это одно из самых охраняемых мест на Земле. Фотографий зданий нет, но мы знаем, что там есть какие-то строения. Зона расположен посреди пустыни, а вокруг нее никого не живет. Однако, если вы приблизитесь слишком близко к объекту, волшебным образом появятся военные и заберут отснятые материалы, задержат вас, либо вежливо попросят покинуть этот район. Сделать фото с воздуха также невозможно, потому что любой объект над зоной будет немедленно сбит. Спутниковых снимков этого места тоже не найти, и никто ничего не знает о нем. Можно услышать предположения, что там прячут инопланетян, но, вероятнее всего, это лишь прикрытие. На самом деле в этой зоне проходят испытания самого современного оружия.
Это одно из самых охраняемых мест на Земле. Фотографий зданий нет, но мы знаем, что там есть какие-то строения. Зона расположен посреди пустыни, а вокруг нее никого не живет. Однако, если вы приблизитесь слишком близко к объекту, волшебным образом появятся военные и заберут отснятые материалы, задержат вас, либо вежливо попросят покинуть этот район. Сделать фото с воздуха также невозможно, потому что любой объект над зоной будет немедленно сбит. Спутниковых снимков этого места тоже не найти, и никто ничего не знает о нем. Можно услышать предположения, что там прячут инопланетян, но, вероятнее всего, это лишь прикрытие. На самом деле в этой зоне проходят испытания самого современного оружия. Форт Нокс – это место, где США хранят все золото, которое у них есть. Он расположен в Кентукки, и является одним из самых крупных золотохранилищ в мире. Здесь и муха не пролетит!
Форт Нокс – это место, где США хранят все золото, которое у них есть. Он расположен в Кентукки, и является одним из самых крупных золотохранилищ в мире. Здесь и муха не пролетит! Это хранилище на глубине 180 м под землей, находится в штате Юта. Оно называется Little Cottonwood Canyon и оснащено датчиками движения и датчиками тепла. Странно, что в США так много секретных и охраняемых мест. Почему у Церкви есть секретное хранилище? Зачем оно нужно?
Это хранилище на глубине 180 м под землей, находится в штате Юта. Оно называется Little Cottonwood Canyon и оснащено датчиками движения и датчиками тепла. Странно, что в США так много секретных и охраняемых мест. Почему у Церкви есть секретное хранилище? Зачем оно нужно? Здесь находится более 25% мирового золота. Эти огромные хранилища расположены на уровне 2,5 м под землей, и их круглосуточно из укрытия охраняет снайпер. Совершить ограбление здесь практически невозможно.
Здесь находится более 25% мирового золота. Эти огромные хранилища расположены на уровне 2,5 м под землей, и их круглосуточно из укрытия охраняет снайпер. Совершить ограбление здесь практически невозможно. Да, вы не ослышались. Это парковка, которая является одним из шести наиболее охраняемых мест в мире. Она предназначена для самых дорогих автомобилей, принадлежащих самым богатым людям мира. Находится парковка в Дербишире (Derbyshire), Англия.
Да, вы не ослышались. Это парковка, которая является одним из шести наиболее охраняемых мест в мире. Она предназначена для самых дорогих автомобилей, принадлежащих самым богатым людям мира. Находится парковка в Дербишире (Derbyshire), Англия. Правительство США говорит, что внутри горы Шайенн ничего нет. Поэтому этот объект очень интересен для нас. Североамериканское Командование по Аэрокосмической Защите (The North American Aerospace Defense Command) использовало эту базу в качестве своей штаб-квартиры, и это самое безопасное место в том случае, если когда-либо случится ядерная война. Чтобы стало понятно: мы не уверены, что в этом бункере ничего нет.
Правительство США говорит, что внутри горы Шайенн ничего нет. Поэтому этот объект очень интересен для нас. Североамериканское Командование по Аэрокосмической Защите (The North American Aerospace Defense Command) использовало эту базу в качестве своей штаб-квартиры, и это самое безопасное место в том случае, если когда-либо случится ядерная война. Чтобы стало понятно: мы не уверены, что в этом бункере ничего нет. Это одно из самых безопасных мест в Европе и, более того, это самое странное место в Европе из-за гигантских объектов, похожих на мячи для гольфа, разбросанных по всей территории Менит-Хилл (Menwith Hill). Это самая большая станция электронного мониторинга на планете.
Это одно из самых безопасных мест в Европе и, более того, это самое странное место в Европе из-за гигантских объектов, похожих на мячи для гольфа, разбросанных по всей территории Менит-Хилл (Menwith Hill). Это самая большая станция электронного мониторинга на планете. Это секретное место – клуб миллионеров. Комплекс занимает площадь в 11 кв. км и находится в Монте-Рио (Monte Rio), штат Калифорния. Его члены представляют собой элиту мира, и они собираются там, чтобы обсудить, кто что знает. Возможно даже мировое господство! Кстати, этот клуб закрыт для женщин.
Это секретное место – клуб миллионеров. Комплекс занимает площадь в 11 кв. км и находится в Монте-Рио (Monte Rio), штат Калифорния. Его члены представляют собой элиту мира, и они собираются там, чтобы обсудить, кто что знает. Возможно даже мировое господство! Кстати, этот клуб закрыт для женщин. Это одно из самых смертоносных и наиболее закрытых мест на нашей планете. Остров находится недалеко от побережья Бразилии и здесь обитают не менее 4000 видов самых опасных змей мира. Считается, что их яд настолько токсичен, что может прожечь вашу кожу. На этот остров могут попасть только ученые.
Это одно из самых смертоносных и наиболее закрытых мест на нашей планете. Остров находится недалеко от побережья Бразилии и здесь обитают не менее 4000 видов самых опасных змей мира. Считается, что их яд настолько токсичен, что может прожечь вашу кожу. На этот остров могут попасть только ученые. Здесь хранится рецепт для популярного напитка Coca-Cola. Это один из самых тщательно охраняемых секретов в мире.
Здесь хранится рецепт для популярного напитка Coca-Cola. Это один из самых тщательно охраняемых секретов в мире. Это специальное хранилище предназначено для хранения семян в случае глобальной экологической катастрофы. Оно находится в Шпицбергене (Spitsbergen), Норвегия.
Это специальное хранилище предназначено для хранения семян в случае глобальной экологической катастрофы. Оно находится в Шпицбергене (Spitsbergen), Норвегия. Это одна из крупнейших в мире библиотек. Здесь содержатся несколько секретных документов, собранных Церковью (Майянские кодексы (Mayan codices), судебный процесс Галилео Галилея и т. д.)
Это одна из крупнейших в мире библиотек. Здесь содержатся несколько секретных документов, собранных Церковью (Майянские кодексы (Mayan codices), судебный процесс Галилео Галилея и т. д.) Эти пещеры расположены во Франции, и в них были обнаружены несколько доисторических пещерных картин. Пещеры были открыты для посещения вплоть до 1963 года. Однако, присутствие человека негативно отразилось на состоянии древних картин на стенах, поэтому теперь пещеры закрыты для публики.
Эти пещеры расположены во Франции, и в них были обнаружены несколько доисторических пещерных картин. Пещеры были открыты для посещения вплоть до 1963 года. Однако, присутствие человека негативно отразилось на состоянии древних картин на стенах, поэтому теперь пещеры закрыты для публики. Комната 39 – это секретная организация, созданная для поиска и получения разными способами иностранной валюты для президента Северной Кореи Ким Чен Ына. Организация была создана в 1970 году, и некоторые говорят, что у нее есть 20 банковских счетов в Китае и Швейцарии, которые они используют для отмывания денег.
Комната 39 – это секретная организация, созданная для поиска и получения разными способами иностранной валюты для президента Северной Кореи Ким Чен Ына. Организация была создана в 1970 году, и некоторые говорят, что у нее есть 20 банковских счетов в Китае и Швейцарии, которые они используют для отмывания денег. Этот секретный ядерный ракетный комплекс в России охраняется двумя российскими батальонами. Это автоматическая база баллистических ракет, которая может быть активирована в случае ядерного удара или сейсмической активности.
Этот секретный ядерный ракетный комплекс в России охраняется двумя российскими батальонами. Это автоматическая база баллистических ракет, которая может быть активирована в случае ядерного удара или сейсмической активности. Это Зона 51 в области высоких технологий! Здесь хранятся данные со всего мира, и вы можете спать спокойно, потому что это место защищено даже лучше, чем настоящая Зона 51. Ваш пароль в Facebook находится в безопасности.
Это Зона 51 в области высоких технологий! Здесь хранятся данные со всего мира, и вы можете спать спокойно, потому что это место защищено даже лучше, чем настоящая Зона 51. Ваш пароль в Facebook находится в безопасности. В 2011 году Япония пострадала от мощнейшего землетрясения и последовавшего за ним цунами. Стихия унесла жизни 16 тысяч человек, которые были совершенно не готовы к тому, чтобы уйти на тот свет так рано. В некоторых городах, которые пострадали от природной катастрофы особенно сильно, местные таксисты стали часто жаловаться на то, что к ним постоянно пытаются подсесть самые настоящие призраки. Юка Кудо (Yuka Kudo), студентка факультета социологии японского университета Тохуко Гакуин (Tohuko Gakuin), в рамках исследований для своей диссертации опросила свыше 100 водителей. Все они верили, что их останавливали реальные пассажиры. Водители включали счетчик и делали записи в журналах, но потом что-то шло не так…
В 2011 году Япония пострадала от мощнейшего землетрясения и последовавшего за ним цунами. Стихия унесла жизни 16 тысяч человек, которые были совершенно не готовы к тому, чтобы уйти на тот свет так рано. В некоторых городах, которые пострадали от природной катастрофы особенно сильно, местные таксисты стали часто жаловаться на то, что к ним постоянно пытаются подсесть самые настоящие призраки. Юка Кудо (Yuka Kudo), студентка факультета социологии японского университета Тохуко Гакуин (Tohuko Gakuin), в рамках исследований для своей диссертации опросила свыше 100 водителей. Все они верили, что их останавливали реальные пассажиры. Водители включали счетчик и делали записи в журналах, но потом что-то шло не так… Привидения, садящиеся в такси, были замечены не только в Японии, но и в Таиланде. 26 декабря 2004 года в Индийском океане произошло сильнейшее землетрясение, вызвавшее смертоносное цунами, которое накрыло побережье Андаманских островов, Таиланда, Индии и других обитаемых зон этой части света. Около 230 тысяч человек погибли в жуткой катастрофе 2004 года, и с тех самых пор местные жители, оставшиеся в живых, начали сообщать о призраках жертв цунами. Через 2 недели после трагедии Лек (Lek), водитель рейсовой маршрутки, рассказал о 7 иностранных туристах, которые сели в его машину и попросили отвезти их на популярный пхукетский пляж Ката (Kata Beach), предложив заплатить ему за услугу 200 бат (местная валюта). Таксист принял заказ, но через какое-то время он внезапно почувствовал онемение во всем теле, оглянулся на задние сидения и понял, что в машине никого нет. В отличие от японских водителей, Лек сказал, что он никак не может справиться с чувством страха и собирается искать другую работу, потому что ему нужно заботиться о своей дочери, а выезжать в ночные смены стало слишком опасно из-за призраков.
Привидения, садящиеся в такси, были замечены не только в Японии, но и в Таиланде. 26 декабря 2004 года в Индийском океане произошло сильнейшее землетрясение, вызвавшее смертоносное цунами, которое накрыло побережье Андаманских островов, Таиланда, Индии и других обитаемых зон этой части света. Около 230 тысяч человек погибли в жуткой катастрофе 2004 года, и с тех самых пор местные жители, оставшиеся в живых, начали сообщать о призраках жертв цунами. Через 2 недели после трагедии Лек (Lek), водитель рейсовой маршрутки, рассказал о 7 иностранных туристах, которые сели в его машину и попросили отвезти их на популярный пхукетский пляж Ката (Kata Beach), предложив заплатить ему за услугу 200 бат (местная валюта). Таксист принял заказ, но через какое-то время он внезапно почувствовал онемение во всем теле, оглянулся на задние сидения и понял, что в машине никого нет. В отличие от японских водителей, Лек сказал, что он никак не может справиться с чувством страха и собирается искать другую работу, потому что ему нужно заботиться о своей дочери, а выезжать в ночные смены стало слишком опасно из-за призраков. Существует множество историй про сверхъестественные предсказания о трагической судьбе Титаника. На удивление в этих пророчествах перечисляются довольно достоверные описания корабля и его легендарного плавания. Но не все знают, что даже сам капитан Эдвард Джон Смит (Edward John Smith) рассказывал о тревожном предчувствии того, что путешествие через Атлантику может пройти не так уж и гладко.
Существует множество историй про сверхъестественные предсказания о трагической судьбе Титаника. На удивление в этих пророчествах перечисляются довольно достоверные описания корабля и его легендарного плавания. Но не все знают, что даже сам капитан Эдвард Джон Смит (Edward John Smith) рассказывал о тревожном предчувствии того, что путешествие через Атлантику может пройти не так уж и гладко. К концу битвы на Сомме (река), которая продлилась почти 4 с половиной месяца, было ранено и погибло около миллиона человек. Вы, наверное, уже подумали, что эта история будет про призраков скончавшихся в бою солдат, но нет. Привидение, о котором пойдет наше повествование, связано с человеком, никогда не участвовавшим в знаменитом бою на Сомме. При жизни уж точно.
К концу битвы на Сомме (река), которая продлилась почти 4 с половиной месяца, было ранено и погибло около миллиона человек. Вы, наверное, уже подумали, что эта история будет про призраков скончавшихся в бою солдат, но нет. Привидение, о котором пойдет наше повествование, связано с человеком, никогда не участвовавшим в знаменитом бою на Сомме. При жизни уж точно. Жители района, находящегося неподалеку от чикагского Международного аэропорта О’Хара (O’Hare International Airport), часто жалуются на появление в их домах странных посетителей. Кто-то постоянно стучит в их двери и пытается объяснить, что ему «нужно найти свой багаж» или «выйти на связь». Прежде чем хозяева дома успевали что-либо понять или вступить в контакт со странным гостем, он исчезал. Вдобавок на ближайшем шоссе водители стали замечать странное свечение и подозрительные фигуры, блуждающие вдоль обочины дороги. Нередко те, кто оставался в самом аэропорту в ожидании своего рейса, позже рассказывали о внезапном похолодании и жутких криках.
Жители района, находящегося неподалеку от чикагского Международного аэропорта О’Хара (O’Hare International Airport), часто жалуются на появление в их домах странных посетителей. Кто-то постоянно стучит в их двери и пытается объяснить, что ему «нужно найти свой багаж» или «выйти на связь». Прежде чем хозяева дома успевали что-либо понять или вступить в контакт со странным гостем, он исчезал. Вдобавок на ближайшем шоссе водители стали замечать странное свечение и подозрительные фигуры, блуждающие вдоль обочины дороги. Нередко те, кто оставался в самом аэропорту в ожидании своего рейса, позже рассказывали о внезапном похолодании и жутких криках. Большинство историй про людей-бабочек из американского города Джоплин звучит практически одинаково. 22 мая 2011 года на Джоплин налетел смертоносный торнадо EF5. Родители с ребенком не успели найти убежище от стихии. Смерч надвигался на беззащитных людей, поднимая в воздух машины и здания, как будто те были невесомыми пушинками, и взрослые уже приготовились к неминуемой смерти. Внезапно жуткий вихрь чудесным образом стих, и семья в итоге осталась невредимой. Ребенок посмотрел на взрослых и спросил: «Правда, они были симпатичными?». Родители такой вопрос не поняли, и тогда ребенок пояснил: «Вы что не видели людей-бабочек?».
Большинство историй про людей-бабочек из американского города Джоплин звучит практически одинаково. 22 мая 2011 года на Джоплин налетел смертоносный торнадо EF5. Родители с ребенком не успели найти убежище от стихии. Смерч надвигался на беззащитных людей, поднимая в воздух машины и здания, как будто те были невесомыми пушинками, и взрослые уже приготовились к неминуемой смерти. Внезапно жуткий вихрь чудесным образом стих, и семья в итоге осталась невредимой. Ребенок посмотрел на взрослых и спросил: «Правда, они были симпатичными?». Родители такой вопрос не поняли, и тогда ребенок пояснил: «Вы что не видели людей-бабочек?». Когда в Лондоне в середине 19 века впервые появилось метро, многие жители города были всерьез обеспокоены тем, что строители прокопали туннели для этого нового вида общественного транспорта слишком глубоко. Горожане переживали, что линии метро могли побеспокоить ад и разозлить самого дьявола. Вдобавок многие пути и сами станции подземки были построены в районе древних захоронений, оставшихся здесь еще со времен пандемии чумы, унесшей в 14 веке жизни миллионов людей.
Когда в Лондоне в середине 19 века впервые появилось метро, многие жители города были всерьез обеспокоены тем, что строители прокопали туннели для этого нового вида общественного транспорта слишком глубоко. Горожане переживали, что линии метро могли побеспокоить ад и разозлить самого дьявола. Вдобавок многие пути и сами станции подземки были построены в районе древних захоронений, оставшихся здесь еще со времен пандемии чумы, унесшей в 14 веке жизни миллионов людей. Неудивительно, что после крупномасштабной трагедии 11 сентября 2001 года, многие люди принялись утверждать, что во время и после серии смертоносных терактов они столкнулись с привидениями. Некоторые выжившие заявили, что в безопасности они оказались только благодаря защите сверхъестественных существ. Один свидетель убежден, что его и других людей, оказавшихся на верхних этажах Северной башни, кто-то буквально протолкнул через стену огня и сопроводил до выхода из здания. Кто? Непонятно… Другой выживший в теракте, пролежавший какое-то время под бетонными блоками, рассказывал о призраке монаха, появившегося рядом с ним под завалами. Призрак успокаивал мужчину и помогал ему дождаться помощи.
Неудивительно, что после крупномасштабной трагедии 11 сентября 2001 года, многие люди принялись утверждать, что во время и после серии смертоносных терактов они столкнулись с привидениями. Некоторые выжившие заявили, что в безопасности они оказались только благодаря защите сверхъестественных существ. Один свидетель убежден, что его и других людей, оказавшихся на верхних этажах Северной башни, кто-то буквально протолкнул через стену огня и сопроводил до выхода из здания. Кто? Непонятно… Другой выживший в теракте, пролежавший какое-то время под бетонными блоками, рассказывал о призраке монаха, появившегося рядом с ним под завалами. Призрак успокаивал мужчину и помогал ему дождаться помощи. Примерно в 23:42 29 декабря 1972 года в районе флоридских болот Эверглейдс (Everglades) разбился рейс 401 Eastern Airlines. Похоже, что незадолго до катастрофы пилоты авиалайнера заметили, что при выпуске шасси у них не загорелась соответствующая лампочка-индикатор, и пока они занимались перепроверкой и поиском неисправности, капитан воздушного судна нечаянно задел штурвал. Это привело к переключению режима автопилота и медленному сбросу высоты. Пилоты не узнали о случившемся, пока не оказалось слишком поздно, и рейс 401 ударился об землю. 75 человек выжило, а 101 человек погиб.
Примерно в 23:42 29 декабря 1972 года в районе флоридских болот Эверглейдс (Everglades) разбился рейс 401 Eastern Airlines. Похоже, что незадолго до катастрофы пилоты авиалайнера заметили, что при выпуске шасси у них не загорелась соответствующая лампочка-индикатор, и пока они занимались перепроверкой и поиском неисправности, капитан воздушного судна нечаянно задел штурвал. Это привело к переключению режима автопилота и медленному сбросу высоты. Пилоты не узнали о случившемся, пока не оказалось слишком поздно, и рейс 401 ударился об землю. 75 человек выжило, а 101 человек погиб. Когда Сорпонгу Пео (Sorpong Peou) было 17 лет, он увидел, как его отца Нама (Nam), государственного служащего, силком затащили в грузовик и увезли в неизвестном направлении. Это произошло в темный период истории Камбоджи, когда в конце 1970-х годов красными кхмерами (коммунистическое течение) было убито около 1,7 миллиона человек. После падения режима в стране было обнаружено 309 массовых захоронений, в которых покоились тела примерно 19 000 человек. Неудивительно, что Нам никогда не вернулся к сыну, и Сорпонг мог только догадываться, что стало с его отцом, или где он похоронен
Когда Сорпонгу Пео (Sorpong Peou) было 17 лет, он увидел, как его отца Нама (Nam), государственного служащего, силком затащили в грузовик и увезли в неизвестном направлении. Это произошло в темный период истории Камбоджи, когда в конце 1970-х годов красными кхмерами (коммунистическое течение) было убито около 1,7 миллиона человек. После падения режима в стране было обнаружено 309 массовых захоронений, в которых покоились тела примерно 19 000 человек. Неудивительно, что Нам никогда не вернулся к сыну, и Сорпонг мог только догадываться, что стало с его отцом, или где он похоронен Корейская бейсбольная команда под названием Hanwha Eagles решила использовать новый подход к привлечению фанатов. Вместо того, чтобы пытаться заманить реальных людей, они просто заполняют свои стадионы роботами.
Корейская бейсбольная команда под названием Hanwha Eagles решила использовать новый подход к привлечению фанатов. Вместо того, чтобы пытаться заманить реальных людей, они просто заполняют свои стадионы роботами. Ассистент по обучению ректальному осмотру – эта не та работа, которая пользуется повышенным спросом, но в Великобритании есть один человек, который зарабатывает на жизнь тем, что позволяет студентам-медикам поковыряться пальцами в своей пятой точке. Или, вернее, если бы и был такой человек, то он недавно потерял бы свою работу из-за робота. Роботизированные ягодицы были созданы работниками лаборатории Имперского колледжа Лондона (Imperial College London).
Ассистент по обучению ректальному осмотру – эта не та работа, которая пользуется повышенным спросом, но в Великобритании есть один человек, который зарабатывает на жизнь тем, что позволяет студентам-медикам поковыряться пальцами в своей пятой точке. Или, вернее, если бы и был такой человек, то он недавно потерял бы свою работу из-за робота. Роботизированные ягодицы были созданы работниками лаборатории Имперского колледжа Лондона (Imperial College London). Роботизированные ягодицы, по-видимому, сейчас являются основным направлением развития робототехники. И их изобретают не просто инженеры-медики, а целая группа экспертов по робототехнике разрабатывает металлическую машину для замены того, что, как выясняется, является довольно важным источником дохода для многих людей: задницу. Компания Samsung использовала искусственные ягодицы для проведения своего «Теста человеческого веса», куда по каким-то причинам не привлекали реальных людей. Им нужен был кто-то, кто сел бы на их телефон, чтобы доказать, что тот не согнется.
Роботизированные ягодицы, по-видимому, сейчас являются основным направлением развития робототехники. И их изобретают не просто инженеры-медики, а целая группа экспертов по робототехнике разрабатывает металлическую машину для замены того, что, как выясняется, является довольно важным источником дохода для многих людей: задницу. Компания Samsung использовала искусственные ягодицы для проведения своего «Теста человеческого веса», куда по каким-то причинам не привлекали реальных людей. Им нужен был кто-то, кто сел бы на их телефон, чтобы доказать, что тот не согнется. В Японии даже младенцев заменяют роботами. Темпы рождаемости падают, все больше и больше молодых людей не создают семьи и остаются с пустотой в душе, которую может заполнить только любовь к ребенку. Или очаровательному карманному роботу. Одно из двух.
В Японии даже младенцев заменяют роботами. Темпы рождаемости падают, все больше и больше молодых людей не создают семьи и остаются с пустотой в душе, которую может заполнить только любовь к ребенку. Или очаровательному карманному роботу. Одно из двух. Когда бывший премьер-министр Таиланда, Йинглук Шинаватра (Yingluck Shinawatra), устала от дешевых подделок тайской кухни по всему миру, она потребовала, чтобы этот вопрос был каким-то образом решен. Она призвала тайское правительство на чрезвычайную заседание, и вместе они приняли решение: им нужен робот. Тайское правительство называет свое создание «e-Delicious», это секретный проект, разработке которого посвятили несколько лет, и представляет он собой робота – кулинарного критика.
Когда бывший премьер-министр Таиланда, Йинглук Шинаватра (Yingluck Shinawatra), устала от дешевых подделок тайской кухни по всему миру, она потребовала, чтобы этот вопрос был каким-то образом решен. Она призвала тайское правительство на чрезвычайную заседание, и вместе они приняли решение: им нужен робот. Тайское правительство называет свое создание «e-Delicious», это секретный проект, разработке которого посвятили несколько лет, и представляет он собой робота – кулинарного критика. Позвонив по горячей линии, вы выслушиваете записанное голосовое сообщение – ничего нового. Такие места оснащены компьютеризированным меню или здесь используются авто-звонки, чтобы связаться со своими клиентами, но одна компания по страхованию жизни, Premier Health Agency, пошла еще дальше. Они сделали робота, чтобы общаться с вами, когда вы просите человека. Компания создала роботизированного телепродавца, запрограммированного на отрицание того, что она робот.
Позвонив по горячей линии, вы выслушиваете записанное голосовое сообщение – ничего нового. Такие места оснащены компьютеризированным меню или здесь используются авто-звонки, чтобы связаться со своими клиентами, но одна компания по страхованию жизни, Premier Health Agency, пошла еще дальше. Они сделали робота, чтобы общаться с вами, когда вы просите человека. Компания создала роботизированного телепродавца, запрограммированного на отрицание того, что она робот. Верите вы в это, или нет, но несколько оригинальных художественных произведений были написаны компьютерами, а одно из них даже попало в шорт-лист конкурса на одну из литературных премий. Одной из первых книг, написанных роботами, был русский роман «Настоящая любовь», а в России он стал одним из самых продаваемых романов года. Тем не менее, он частично исчез с полок, потому, что робота-автора стали рассматривать как некий маркетинговый трюк. Вот почему самой невероятной историей должна стать метко названная японская работа : «День, когда компьютер написал книгу».
Верите вы в это, или нет, но несколько оригинальных художественных произведений были написаны компьютерами, а одно из них даже попало в шорт-лист конкурса на одну из литературных премий. Одной из первых книг, написанных роботами, был русский роман «Настоящая любовь», а в России он стал одним из самых продаваемых романов года. Тем не менее, он частично исчез с полок, потому, что робота-автора стали рассматривать как некий маркетинговый трюк. Вот почему самой невероятной историей должна стать метко названная японская работа : «День, когда компьютер написал книгу». Народ Хунну, проживавший к северу от Великой стены, состоял из разрозненных групп кочевников. Это не помешало им объединиться в единую нацию за три года до основания династии Хан в 209 году до н.э. После продолжительного периода, во время которого эти ранние монголы громили повсюду ранних китайцев, в 162 г. до н.э., наконец, установился мир.
Народ Хунну, проживавший к северу от Великой стены, состоял из разрозненных групп кочевников. Это не помешало им объединиться в единую нацию за три года до основания династии Хан в 209 году до н.э. После продолжительного периода, во время которого эти ранние монголы громили повсюду ранних китайцев, в 162 г. до н.э., наконец, установился мир. В Монголии может быть довольно холодно, настолько, что продавцы мороженого смогут с радостью продавать свой товар непосредственно из картонных контейнеров, не нуждаясь в морозильной камере. История гласит, что задолго до того, как Марко Поло вернулся в Италию с этим вкусным деликатесом, зимой всадники брали с собой в длительное путешествие по пустыне Гоби сливки, поместив их в емкости, изготовленные из кишок животных. Во время езды жидкие сливки энергично встряхивались при минусовых температурах, в результате чего они сразу замерзали и перемешивались.
В Монголии может быть довольно холодно, настолько, что продавцы мороженого смогут с радостью продавать свой товар непосредственно из картонных контейнеров, не нуждаясь в морозильной камере. История гласит, что задолго до того, как Марко Поло вернулся в Италию с этим вкусным деликатесом, зимой всадники брали с собой в длительное путешествие по пустыне Гоби сливки, поместив их в емкости, изготовленные из кишок животных. Во время езды жидкие сливки энергично встряхивались при минусовых температурах, в результате чего они сразу замерзали и перемешивались. Почти 150 лет Улан-Батор был мобильной столицей. Как и можно было предположить, для людей с тысячелетней историей жизни кочевников было бы довольно скучно сидеть на одном месте. Поэтому, когда выдвигался Хан, за ним следовал весь город. Первоначально известный как Дворец-Юрт (Örgöö), город 25 раз менял свое местоположение прежде, чем окончательно остановиться там, где встречаются реки Селбе (Selbe) и Туул (Tuul).
Почти 150 лет Улан-Батор был мобильной столицей. Как и можно было предположить, для людей с тысячелетней историей жизни кочевников было бы довольно скучно сидеть на одном месте. Поэтому, когда выдвигался Хан, за ним следовал весь город. Первоначально известный как Дворец-Юрт (Örgöö), город 25 раз менял свое местоположение прежде, чем окончательно остановиться там, где встречаются реки Селбе (Selbe) и Туул (Tuul). Совершенно очевидно, что почти каждая страна на Земле имеет несколько миллионов скелетов в шкафу, и было бы неправильно не упомянуть о вкладе Великого Хана в “благородное искусство” истребления людей. Только во время Геноцида армян монголы побили самый высокий рекорд в массовом убийстве, который не имел себе равных вплоть до появления огнестрельного и химического оружия.
Совершенно очевидно, что почти каждая страна на Земле имеет несколько миллионов скелетов в шкафу, и было бы неправильно не упомянуть о вкладе Великого Хана в “благородное искусство” истребления людей. Только во время Геноцида армян монголы побили самый высокий рекорд в массовом убийстве, который не имел себе равных вплоть до появления огнестрельного и химического оружия. Лошадь Пржевальского, названная в честь поляка, который «обнаружил» эту породу в XIX веке, известна в Монголии как тахи. Из-за того, что она была редкой, а люди были чудовищами, лошадь в Монголии практически исчезла, так как ее стали активно отлавливать для зоопарков и других нужд. Круто, ничего не скажешь! И дальше будет еще интереснее.
Лошадь Пржевальского, названная в честь поляка, который «обнаружил» эту породу в XIX веке, известна в Монголии как тахи. Из-за того, что она была редкой, а люди были чудовищами, лошадь в Монголии практически исчезла, так как ее стали активно отлавливать для зоопарков и других нужд. Круто, ничего не скажешь! И дальше будет еще интереснее. Если где-нибудь на планете и есть страна, которая доказывает, что не все политические системы работают, то это Монголия. После того, как 1924 она стала плотно сотрудничать с СССР, являясь вторым коммунистическим государством в мире, у Монголии была определенная степень автономии. Это было разрешено по нескольким причинам.
Если где-нибудь на планете и есть страна, которая доказывает, что не все политические системы работают, то это Монголия. После того, как 1924 она стала плотно сотрудничать с СССР, являясь вторым коммунистическим государством в мире, у Монголии была определенная степень автономии. Это было разрешено по нескольким причинам. Монголия – это всего лишь два человека на квадратный километр, отличное место для затворников, отшельников, асоциальных чудаков или писателей. Единственная проблема заключается в том, что делать с тем другим парнем, оказавшимся на территории вашего квадратного километра. Убить? Оставить его замерзать до смерти в 30-градусный мороз? Победить его на битве Батл-Як (Battle-Yak)? Выбор за вами.
Монголия – это всего лишь два человека на квадратный километр, отличное место для затворников, отшельников, асоциальных чудаков или писателей. Единственная проблема заключается в том, что делать с тем другим парнем, оказавшимся на территории вашего квадратного километра. Убить? Оставить его замерзать до смерти в 30-градусный мороз? Победить его на битве Батл-Як (Battle-Yak)? Выбор за вами. Недалеко от Улан-Батора находится статуя Чингисхана высотой 40 м. Мы можем понять, почему: он основал страну, но он также убил миллионы людей. Это очень похоже на статую Ленина в Сиэтле. Конечно, все здесь полагают, что он классный парень, но вот массовые убийства – это проблематично. Естественно, мы не должны забывать, что 12-й век – совсем иное время, и тогда стрелять из лука было слишком круто, чтобы от этого отказываться.
Недалеко от Улан-Батора находится статуя Чингисхана высотой 40 м. Мы можем понять, почему: он основал страну, но он также убил миллионы людей. Это очень похоже на статую Ленина в Сиэтле. Конечно, все здесь полагают, что он классный парень, но вот массовые убийства – это проблематично. Естественно, мы не должны забывать, что 12-й век – совсем иное время, и тогда стрелять из лука было слишком круто, чтобы от этого отказываться. Забудьте про ралли Париж-Дакар или компьютерную игру «Безумные гонки». Самая дикая гонка на Земле стартует оттуда, где вы сейчас находитесь, до паба в Монголии. Правила странные: ваш двигатель должен быть менее одного литра, если только вы не передвигаетесь на каком-нибудь «веселом» автомобиле. Как, например, машина скорой помощи или что-то в этом роде. Вы также можете ездить на мотоцикле, но объем его двигателя должен быть меньше 125 см. куб.
Забудьте про ралли Париж-Дакар или компьютерную игру «Безумные гонки». Самая дикая гонка на Земле стартует оттуда, где вы сейчас находитесь, до паба в Монголии. Правила странные: ваш двигатель должен быть менее одного литра, если только вы не передвигаетесь на каком-нибудь «веселом» автомобиле. Как, например, машина скорой помощи или что-то в этом роде. Вы также можете ездить на мотоцикле, но объем его двигателя должен быть меньше 125 см. куб. Для тех из нас, кому не посчастливилось жить в так называемых развитых странах, есть только несколько вещей, более романтичных, чем вид представителей казахского народа в Монголии, охотящихся с орлами, которых называют «Золотыми орлами». Огромных птиц приручили и охотились с ними в степях на протяжении более 4500 лет. Это невероятный пример силы традиции и культуры.
Для тех из нас, кому не посчастливилось жить в так называемых развитых странах, есть только несколько вещей, более романтичных, чем вид представителей казахского народа в Монголии, охотящихся с орлами, которых называют «Золотыми орлами». Огромных птиц приручили и охотились с ними в степях на протяжении более 4500 лет. Это невероятный пример силы традиции и культуры.





 Не часто можно встретить древнего гончара с чувством юмора. 4000-летний горшок заставил археологов улыбнуться из-за того, что они обнаружили на его поверхности. Сначала, когда его нашли в 2017 году при раскопках в Турции недалеко от сирийской границы, не было замечено ничего необычного. Это был очередной разбитый сосуд с места, где в течение 7 лет велись раскопки и было обнаружено множество артефактов. Команда реставраторов собрала все фрагменты в большой пузатый горшок и тогда проявилось кое-что, очень знакомое людям сегодня. Смайлик.
Не часто можно встретить древнего гончара с чувством юмора. 4000-летний горшок заставил археологов улыбнуться из-за того, что они обнаружили на его поверхности. Сначала, когда его нашли в 2017 году при раскопках в Турции недалеко от сирийской границы, не было замечено ничего необычного. Это был очередной разбитый сосуд с места, где в течение 7 лет велись раскопки и было обнаружено множество артефактов. Команда реставраторов собрала все фрагменты в большой пузатый горшок и тогда проявилось кое-что, очень знакомое людям сегодня. Смайлик. В 2000-х годах бразильские геологи стали находить странные пещеры. Они располагались уровнями и включали длинные арочные туннели, которые вливались в сложные подземные сети выходов, камер и проходов. Похоже, они не были результатом какого-либо природного геологического явления. То, что было обнаружено на потолках и стенах, стало ключом к отгадке. Большие борозды пересекали поверхность, и более пристальное изучение заставило сделать вывод, что это следы древних когтей.
В 2000-х годах бразильские геологи стали находить странные пещеры. Они располагались уровнями и включали длинные арочные туннели, которые вливались в сложные подземные сети выходов, камер и проходов. Похоже, они не были результатом какого-либо природного геологического явления. То, что было обнаружено на потолках и стенах, стало ключом к отгадке. Большие борозды пересекали поверхность, и более пристальное изучение заставило сделать вывод, что это следы древних когтей. Необычный корабль был найден вблизи реки Дебен (River Deben) в Англии. В то время, как на нем присутствовали следы, оставшиеся после эксплуатации по прямому назначению, 27-метровый корабль использовался в качестве гробницы. Открытие произошло восемь десятилетий назад на Саттон-Ху (Sutton Hoo), древнем кладбище и одном из самых важных мест захоронения в Британии.
Необычный корабль был найден вблизи реки Дебен (River Deben) в Англии. В то время, как на нем присутствовали следы, оставшиеся после эксплуатации по прямому назначению, 27-метровый корабль использовался в качестве гробницы. Открытие произошло восемь десятилетий назад на Саттон-Ху (Sutton Hoo), древнем кладбище и одном из самых важных мест захоронения в Британии. В 2005 году команда реставраторов Фитвильямовского музея искусства и древностей в Кембридже (Cambridge Fitzwilliam Museum) работала над восстановлением гроба из Египта. Он принадлежал священнику по имени Неспавершефит (Nespawershefyt), который умер около 1000 г. до н.э. Кто-то заглянул под крышку и обнаружил отпечатки пальцев ремесленника, изготовившего гроб. Они совершенно точно не принадлежали грязным пальцам одного из реставраторов, а остались после тех, кто изготовил гроб 3000 лет назад. По какой-то причине древние рабочие обработали внутреннюю поверхность крышки, прежде чем лак высох. В результате их нетерпение сохранило пару отпечатков пальцев для потомков.
В 2005 году команда реставраторов Фитвильямовского музея искусства и древностей в Кембридже (Cambridge Fitzwilliam Museum) работала над восстановлением гроба из Египта. Он принадлежал священнику по имени Неспавершефит (Nespawershefyt), который умер около 1000 г. до н.э. Кто-то заглянул под крышку и обнаружил отпечатки пальцев ремесленника, изготовившего гроб. Они совершенно точно не принадлежали грязным пальцам одного из реставраторов, а остались после тех, кто изготовил гроб 3000 лет назад. По какой-то причине древние рабочие обработали внутреннюю поверхность крышки, прежде чем лак высох. В результате их нетерпение сохранило пару отпечатков пальцев для потомков. Египтяне серьезно относились к цветам и наделяли каждый определенным смыслом и качествами. Исследователи знали, что зеленый цвет представляет собой рост, урожай и здоровье. Он был достаточно важным, чтобы его в виде вырезанного жука-скарабея поместили у самого сердца мумии. Но никто даже не подозревал, почему зеленый цвет также очень важен, когда речь идет о египетских детях. Согласно древним записям и иероглифам, молодежь даже носила зеленый макияж.
Египтяне серьезно относились к цветам и наделяли каждый определенным смыслом и качествами. Исследователи знали, что зеленый цвет представляет собой рост, урожай и здоровье. Он был достаточно важным, чтобы его в виде вырезанного жука-скарабея поместили у самого сердца мумии. Но никто даже не подозревал, почему зеленый цвет также очень важен, когда речь идет о египетских детях. Согласно древним записям и иероглифам, молодежь даже носила зеленый макияж. Когда археолог Андрей Белинский расчищал место захоронения, он обнаружил то, что затем годами держал в секрете. Расположенное в России, это место было курганом, скифской могилой. Скифы были грозными кочевниками, которые не оставили после себя ничего, кроме тысяч курганов. Поэтому любая новая информация об их культуре очень ценна. В 2013 году команда Белинского нашла скрытую комнату с золотыми украшениями и сосудами. Это 2400-летнее сокровище было полным сюрпризом. Чтобы избежать мародерства, о находке широко не сообщалось.
Когда археолог Андрей Белинский расчищал место захоронения, он обнаружил то, что затем годами держал в секрете. Расположенное в России, это место было курганом, скифской могилой. Скифы были грозными кочевниками, которые не оставили после себя ничего, кроме тысяч курганов. Поэтому любая новая информация об их культуре очень ценна. В 2013 году команда Белинского нашла скрытую комнату с золотыми украшениями и сосудами. Это 2400-летнее сокровище было полным сюрпризом. Чтобы избежать мародерства, о находке широко не сообщалось. В Италии обитатели мужского монастыря в Фоллони (Folloni) столкнулись с суровой и голодной зимой. Согласно 700-летней легенде, однажды ночью ангел принес хлеб и оставил его на пороге монастыря. Благодетель монахов не был ангелом. Они считали, что пищу принес Святой Франциск Ассизский (Saint Francis of Assisi), который был во Франции в то время. Монахи хранили хлебный мешок в течение семи столетий. Ученые решили выяснить, действительно ли реликвия является такой древней и, если получится, найти следы того, что на самом деле в ней когда-то лежало.
В Италии обитатели мужского монастыря в Фоллони (Folloni) столкнулись с суровой и голодной зимой. Согласно 700-летней легенде, однажды ночью ангел принес хлеб и оставил его на пороге монастыря. Благодетель монахов не был ангелом. Они считали, что пищу принес Святой Франциск Ассизский (Saint Francis of Assisi), который был во Франции в то время. Монахи хранили хлебный мешок в течение семи столетий. Ученые решили выяснить, действительно ли реликвия является такой древней и, если получится, найти следы того, что на самом деле в ней когда-то лежало. Еще один религиозный артефакт из Италии, города Россано (Rossano), является частью Библии, и называется Кодексом Пурпуреус Россаненсис (Codex Purpureus Rossanensis). Содержащая только Евангелия от Матфея и Марка, 1500-летняя книга относится к числу самых древних новозаветных освещенных рукописей. Ученые долго размышляли, как появились прекрасные фиолетовые страницы. В то время сделать красители было очень трудно. Предполагалось, что пергамент был обработан по известной технологии того времени с использованием экстракта улитки, который продуцировал фиолетовый цвет.
Еще один религиозный артефакт из Италии, города Россано (Rossano), является частью Библии, и называется Кодексом Пурпуреус Россаненсис (Codex Purpureus Rossanensis). Содержащая только Евангелия от Матфея и Марка, 1500-летняя книга относится к числу самых древних новозаветных освещенных рукописей. Ученые долго размышляли, как появились прекрасные фиолетовые страницы. В то время сделать красители было очень трудно. Предполагалось, что пергамент был обработан по известной технологии того времени с использованием экстракта улитки, который продуцировал фиолетовый цвет. В 2010 году Египетский Высший Совет по Древностям (Egypt’s Supreme Council of Antiquities) пережил настоящую панику. В гробнице Тутанхамона происходило нечто, что не поддавалось объяснению. Коричневые пятна повредили почти все поверхности, изуродовав картины, штукатурку и даже серебро. Полагая, что дыхание туристов стимулировало рост микробов, совет вызвал экспертов из Лос-Анджелеса. Пятна, действительно, были микробами, но давно уже мертвыми. Микроорганизмы представляли собой двойную загадку. Анализ ДНК не смог идентифицировать их, кроме того, что они относились к классу грибков. Во-вторых, их присутствие добавило новый поворот к истории таинственного фараона.
В 2010 году Египетский Высший Совет по Древностям (Egypt’s Supreme Council of Antiquities) пережил настоящую панику. В гробнице Тутанхамона происходило нечто, что не поддавалось объяснению. Коричневые пятна повредили почти все поверхности, изуродовав картины, штукатурку и даже серебро. Полагая, что дыхание туристов стимулировало рост микробов, совет вызвал экспертов из Лос-Анджелеса. Пятна, действительно, были микробами, но давно уже мертвыми. Микроорганизмы представляли собой двойную загадку. Анализ ДНК не смог идентифицировать их, кроме того, что они относились к классу грибков. Во-вторых, их присутствие добавило новый поворот к истории таинственного фараона. Еще один фиолетовый пигмент повреждает свитки во всем мире. Древние книжники никогда не добавляли цвет, поскольку его сложно было контролировать, он мог скрыть древние письмена и разрушить пергамент. Чтобы разобраться в природе вредоносных пятен, исследователи изучили поврежденную книгу из секретных архивов Ватикана. Свиток изготовлен из козьей шкуры – это петиция диной 5 м, написанная в 1244 году нашей эры. Его края окрашены в фиолетовый, а некоторые страницы полностью испорчены этим пигментом. Изучая микробов, исследователи брали соскобы, чтобы установить последовательность генов. В отличие от таинственного организма в могиле Тутанхамона, этот удалось идентифицировать.
Еще один фиолетовый пигмент повреждает свитки во всем мире. Древние книжники никогда не добавляли цвет, поскольку его сложно было контролировать, он мог скрыть древние письмена и разрушить пергамент. Чтобы разобраться в природе вредоносных пятен, исследователи изучили поврежденную книгу из секретных архивов Ватикана. Свиток изготовлен из козьей шкуры – это петиция диной 5 м, написанная в 1244 году нашей эры. Его края окрашены в фиолетовый, а некоторые страницы полностью испорчены этим пигментом. Изучая микробов, исследователи брали соскобы, чтобы установить последовательность генов. В отличие от таинственного организма в могиле Тутанхамона, этот удалось идентифицировать. Консервативная медицина придерживается мнения, что нервы передают информацию посредством электрических импульсов. Они представляют собой дорожки, по которым мозг связывается со всем остальным телом, и их даже можно назвать гонцами, передающими руке команду погладить кошку или взять чашку с кофе, например. Однако для физиков это звучит крайне непонятно. Термодинамические законы утверждают, что электрические импульсы производят тепло, но внутри человеческого тела такое тепло никто пока что не регистрировал. Поэтому ученые высказали другое предположение – нервы на самом деле используют не электричество. Вместо этого они общаются с помощью звуковых волн. Не все ученые согласны с такой теорией, но она вполне может объяснить стародавнюю медицинскую загадку.
Консервативная медицина придерживается мнения, что нервы передают информацию посредством электрических импульсов. Они представляют собой дорожки, по которым мозг связывается со всем остальным телом, и их даже можно назвать гонцами, передающими руке команду погладить кошку или взять чашку с кофе, например. Однако для физиков это звучит крайне непонятно. Термодинамические законы утверждают, что электрические импульсы производят тепло, но внутри человеческого тела такое тепло никто пока что не регистрировал. Поэтому ученые высказали другое предположение – нервы на самом деле используют не электричество. Вместо этого они общаются с помощью звуковых волн. Не все ученые согласны с такой теорией, но она вполне может объяснить стародавнюю медицинскую загадку. Во время эксперимента поведение обезьян привело к невероятному открытию. Сначала животных научили тянуться к свету, когда на специальном табло загоралась лампочка. Когда луч был ярким, обезьяны реагировали на него незамедлительно. Когда лампочка светила тускло, приматам становилось сложнее выполнить поставленную перед ними задачу. Однако если неяркий свет сопровождался резким звуковым сигналом, обезьяны реагировали на луч молниеносно, что позволило сделать вывод о том, что мозг может использовать даже звук, чтобы «видеть».
Во время эксперимента поведение обезьян привело к невероятному открытию. Сначала животных научили тянуться к свету, когда на специальном табло загоралась лампочка. Когда луч был ярким, обезьяны реагировали на него незамедлительно. Когда лампочка светила тускло, приматам становилось сложнее выполнить поставленную перед ними задачу. Однако если неяркий свет сопровождался резким звуковым сигналом, обезьяны реагировали на луч молниеносно, что позволило сделать вывод о том, что мозг может использовать даже звук, чтобы «видеть». Анализы крови – один из важнейших способов постановки правильного диагноза, но и здесь не обходится без своих сложностей. Нынешние технологии изучения образцов крови затратные по времени, и существует ряд рисков, включая заражение и повреждение пробы. К тому же доставка крови – тоже не всегда легко осуществимая задача.
Анализы крови – один из важнейших способов постановки правильного диагноза, но и здесь не обходится без своих сложностей. Нынешние технологии изучения образцов крови затратные по времени, и существует ряд рисков, включая заражение и повреждение пробы. К тому же доставка крови – тоже не всегда легко осуществимая задача. Чем только не пытались объяснить любители головоломок способность буддистских монахов парить над землей. Среди версий предлагались теории про магниты и даже про лазеры. Оказывается, что ответ кроется в беззвучном шуме… В 2014 году научные сотрудники из одного шотландского университета обнаружили, что звуковая перкуссия способна поднимать в воздух целые объекты.
Чем только не пытались объяснить любители головоломок способность буддистских монахов парить над землей. Среди версий предлагались теории про магниты и даже про лазеры. Оказывается, что ответ кроется в беззвучном шуме… В 2014 году научные сотрудники из одного шотландского университета обнаружили, что звуковая перкуссия способна поднимать в воздух целые объекты. Сначала профессора Университета Джорджа Мейсона из Виргинии (George Mason University in Virginia) отнеслись к проекту двух своих студентов довольно скептически. Пара юных инженеров хотела научиться «оглушать» огонь с помощью звуковых волн. Предыдущие исследования на эту тему вдохновили молодых ученых на создание огнетушителя, оснащенного специальной звуковой установкой.
Сначала профессора Университета Джорджа Мейсона из Виргинии (George Mason University in Virginia) отнеслись к проекту двух своих студентов довольно скептически. Пара юных инженеров хотела научиться «оглушать» огонь с помощью звуковых волн. Предыдущие исследования на эту тему вдохновили молодых ученых на создание огнетушителя, оснащенного специальной звуковой установкой. Оказывается, что низкочастотные звуковые волны не только тушат пожары. Они также связаны с восприятием горького вкуса еды, а высокие частоты наоборот играют роль в ощущении сладости.
Оказывается, что низкочастотные звуковые волны не только тушат пожары. Они также связаны с восприятием горького вкуса еды, а высокие частоты наоборот играют роль в ощущении сладости. Марк Баллора (Mark Ballora) вырос в семье музыкантов. Позже во время учебы в университете и в процессе получения своей научной степени мужчина заинтересовался в преобразовании информации в музыку. В итоге Баллора пришел к сонификации, методу выражения математических данных в формате звуковых волн.
Марк Баллора (Mark Ballora) вырос в семье музыкантов. Позже во время учебы в университете и в процессе получения своей научной степени мужчина заинтересовался в преобразовании информации в музыку. В итоге Баллора пришел к сонификации, методу выражения математических данных в формате звуковых волн. Когда исследователи захотели понять суть феномена под названием «Эффект коктейльной вечеринки», они обратили свое внимание на больных эпилепсией. Эти пациенты обладали кое-чем очень ценным для науки – у некоторых из них в терапевтических целях в мозг уже были установлены специальные электроды.
Когда исследователи захотели понять суть феномена под названием «Эффект коктейльной вечеринки», они обратили свое внимание на больных эпилепсией. Эти пациенты обладали кое-чем очень ценным для науки – у некоторых из них в терапевтических целях в мозг уже были установлены специальные электроды. Среди людей, страдающих от бессонницы, существует термин «белый шум», которые они иногда употребляют в отношении хорошего ночного отдыха. Это также способность блокировать фоновые помехи и игнорировать их, концентрируясь на более приоритетных задачах. Например, вы легко забываете о звуке работающего вентилятора, когда заняты чем-то важным. Но недавно ряд независимых исследований обнаружил кое-что полюбопытнее для тех, у кого проблемы со сном, – розовый шум.
Среди людей, страдающих от бессонницы, существует термин «белый шум», которые они иногда употребляют в отношении хорошего ночного отдыха. Это также способность блокировать фоновые помехи и игнорировать их, концентрируясь на более приоритетных задачах. Например, вы легко забываете о звуке работающего вентилятора, когда заняты чем-то важным. Но недавно ряд независимых исследований обнаружил кое-что полюбопытнее для тех, у кого проблемы со сном, – розовый шум. Для тех, кто любит розовый шум или рок-концерты, это может прозвучать абсолютно невероятно, но в мире существуют люди, которые не переносят звук лопающихся пузырьков упаковочной пленки. Да-да, щелканье шариковой ручкой может вызвать у кого-то учащенное сердцебиение и потливость, настолько сильно их будет раздражать этот посторонний звук.
Для тех, кто любит розовый шум или рок-концерты, это может прозвучать абсолютно невероятно, но в мире существуют люди, которые не переносят звук лопающихся пузырьков упаковочной пленки. Да-да, щелканье шариковой ручкой может вызвать у кого-то учащенное сердцебиение и потливость, настолько сильно их будет раздражать этот посторонний звук. Это вполне официальное название, и звучит оно довольно правдиво, потому что бобровая струя – это химическое соединение, выделяемое бобрами, причем не абы чем, а их прианальными желёзами. Чаще всего это вещество используется для усиления запаха малиновых конфеток, но оно встречается также и в составе препаратов, духов и афродизиаков.
Это вполне официальное название, и звучит оно довольно правдиво, потому что бобровая струя – это химическое соединение, выделяемое бобрами, причем не абы чем, а их прианальными желёзами. Чаще всего это вещество используется для усиления запаха малиновых конфеток, но оно встречается также и в составе препаратов, духов и афродизиаков. Используется обычно для улучшения вкуса и разрыхления теста. Бромат калия заодно причислен к канцерогенам группы 2B (возможный канцероген), и именно благодаря ему ваши сэндвичи такие вкусные. В наши дни на него ввели запрет в ЕС, Канаде, Нигерии, Бразилии, Перу и даже в Китае.
Используется обычно для улучшения вкуса и разрыхления теста. Бромат калия заодно причислен к канцерогенам группы 2B (возможный канцероген), и именно благодаря ему ваши сэндвичи такие вкусные. В наши дни на него ввели запрет в ЕС, Канаде, Нигерии, Бразилии, Перу и даже в Китае. В списке самых опасных товаров по версии ООН каменноугольная смола идет под номером 199. Раньше это вещество было самым распространенным источником пищевого красителя под названием «Красный очаровательный АС». К счастью, в современных продуктах искусственный краситель красного цвета получают теперь из нефти, что намного безопаснее.
В списке самых опасных товаров по версии ООН каменноугольная смола идет под номером 199. Раньше это вещество было самым распространенным источником пищевого красителя под названием «Красный очаровательный АС». К счастью, в современных продуктах искусственный краситель красного цвета получают теперь из нефти, что намного безопаснее. Это вещество производят самки насекомых-червецов, и используется оно для лакировки поверхностей, чаще всего древесины и конфеток Skittles.
Это вещество производят самки насекомых-червецов, и используется оно для лакировки поверхностей, чаще всего древесины и конфеток Skittles. Такой ингредиент вряд ли кого-то удивит, но оказывается, что его применяют и в приготовлении американских пирожных Twinkies (золотой бисквит с кремовым наполнителем). В общем если вы вегетарианец, то этот десерт вам явно не подойдет.
Такой ингредиент вряд ли кого-то удивит, но оказывается, что его применяют и в приготовлении американских пирожных Twinkies (золотой бисквит с кремовым наполнителем). В общем если вы вегетарианец, то этот десерт вам явно не подойдет. Мало кто еще не слышал о вреде этого ингредиента, а ведь он встречается довольно часто. Или же глутамат натрия не такой уж и опасный? Долгие годы это вещество обвиняли в некоторых случаях пищевых отравлений, но на самом деле большинство примеров из этого списка намного опаснее этого усилителя вкуса…
Мало кто еще не слышал о вреде этого ингредиента, а ведь он встречается довольно часто. Или же глутамат натрия не такой уж и опасный? Долгие годы это вещество обвиняли в некоторых случаях пищевых отравлений, но на самом деле большинство примеров из этого списка намного опаснее этого усилителя вкуса… Этот пищевой краситель запрещен в нескольких странах мира, включая Австралию и в прошлом Норвегию. Производные тартразина используются в пищевой промышленности для получения самых разных цветов продуктов. Негативное воздействие на человеческий организм у этой добавки носит относительный характер, хотя во время лабораторных экспериментов у молодых мышей после его употребления были отмечены нарушения в работе нервной системы.
Этот пищевой краситель запрещен в нескольких странах мира, включая Австралию и в прошлом Норвегию. Производные тартразина используются в пищевой промышленности для получения самых разных цветов продуктов. Негативное воздействие на человеческий организм у этой добавки носит относительный характер, хотя во время лабораторных экспериментов у молодых мышей после его употребления были отмечены нарушения в работе нервной системы. Азодикарбонамид – это, по сути, отбеливатель муки, довольно часто используемый в пищевой промышленности. Вдобавок это соединение применяется в производстве пластика и синтетической кожи. К несчастью, его связывают с дыхательной недостаточностью, поэтому в Великобритании продукты с азодикарбонамидом должны быть помечены специальными знаками.
Азодикарбонамид – это, по сути, отбеливатель муки, довольно часто используемый в пищевой промышленности. Вдобавок это соединение применяется в производстве пластика и синтетической кожи. К несчастью, его связывают с дыхательной недостаточностью, поэтому в Великобритании продукты с азодикарбонамидом должны быть помечены специальными знаками. В Америке этот сироп стал практически главным подсластителем и во многих домах давно заменил обычный столовый сахар. Этот продукт намного дешевле привычной сахарозы, ведь с кукурузой в США точно нет проблем.
В Америке этот сироп стал практически главным подсластителем и во многих домах давно заменил обычный столовый сахар. Этот продукт намного дешевле привычной сахарозы, ведь с кукурузой в США точно нет проблем. Известная также как альгинат пропиленгликоля, добавка E405 используется в качестве загустителя, стабилизатора и эмульгатора. Но это еще не все. Это вещество также можно встретить в автомобильном антифризе и в составе средств от обледенения самолетов…
Известная также как альгинат пропиленгликоля, добавка E405 используется в качестве загустителя, стабилизатора и эмульгатора. Но это еще не все. Это вещество также можно встретить в автомобильном антифризе и в составе средств от обледенения самолетов… Это вещество получают из морских водорослей и иногда используют в качестве растительной альтернативы желатину, а также в производстве некоторых мясных и молочных продуктов. Долгосрочные последствия употребления каррагинана пока что неизвестны.
Это вещество получают из морских водорослей и иногда используют в качестве растительной альтернативы желатину, а также в производстве некоторых мясных и молочных продуктов. Долгосрочные последствия употребления каррагинана пока что неизвестны. Скорее всего, именно благодаря этой пищевой добавке ваша любимая газировка такая вкусная и немного кислит. Ортофосфорная кислота привлекательна своей низкой стоимостью, но она также связана со снижением плотности костей и заболеваниями почек.
Скорее всего, именно благодаря этой пищевой добавке ваша любимая газировка такая вкусная и немного кислит. Ортофосфорная кислота привлекательна своей низкой стоимостью, но она также связана со снижением плотности костей и заболеваниями почек. Об этой добавке ведется очень много споров, ведь безопасность бычьего гормона роста для здоровья человека – тема неоднозначная. Кстати, США сегодня – практически последняя развитая страна, в которой не запрещено производство и продажа молока, которое дают коровы, выращенные на рекомбинантном бычьем соматотропине (искусственный гормон роста). А вы любите молоко?
Об этой добавке ведется очень много споров, ведь безопасность бычьего гормона роста для здоровья человека – тема неоднозначная. Кстати, США сегодня – практически последняя развитая страна, в которой не запрещено производство и продажа молока, которое дают коровы, выращенные на рекомбинантном бычьем соматотропине (искусственный гормон роста). А вы любите молоко? Желатин производят из коллагена кожи и костей животных. Это вещество очень часто используется в косметологии, пищевой промышленности (зефир, йогурты, желе) и в качестве гелеобразующей смеси в области фотографии.
Желатин производят из коллагена кожи и костей животных. Это вещество очень часто используется в косметологии, пищевой промышленности (зефир, йогурты, желе) и в качестве гелеобразующей смеси в области фотографии. Наверное, мало удивительного в том, что иногда небольшое количество минеральных удобрений попадает на фрукты и овощи. Однако если вы любите сэндвичи, это соединение вам знакомо не только в качестве удобрения почв, ведь дрожжевое тесто получается таким вкусным именно благодаря сульфату аммония. Кстати, в порошковых огнетушителях и огнезащитных средствах это вещество тоже очень часто встречается.
Наверное, мало удивительного в том, что иногда небольшое количество минеральных удобрений попадает на фрукты и овощи. Однако если вы любите сэндвичи, это соединение вам знакомо не только в качестве удобрения почв, ведь дрожжевое тесто получается таким вкусным именно благодаря сульфату аммония. Кстати, в порошковых огнетушителях и огнезащитных средствах это вещество тоже очень часто встречается. Этот популярный консервант добавляется в мясо, хот-доги и другие продукты питания. Его также используют для изготовления дымовых шашек и в пиротехническом деле. Согласно некоторым исследованиям нитрит натрия может быть связан с риском возникновения заболеваний сердца.
Этот популярный консервант добавляется в мясо, хот-доги и другие продукты питания. Его также используют для изготовления дымовых шашек и в пиротехническом деле. Согласно некоторым исследованиям нитрит натрия может быть связан с риском возникновения заболеваний сердца. Хочется верить, что в своей еде вы никогда не обнаружите это вещество. Однако его нередко используют для производства пластика, в котором хранятся продукты питания. Влияние этого соединения на здоровье людей до сих пор не до конца изучено, но существуют опасения, что оно может быть вредным для младенцев, которых кормят молоком из пластиковых бутылочек и детским питанием из баночек.
Хочется верить, что в своей еде вы никогда не обнаружите это вещество. Однако его нередко используют для производства пластика, в котором хранятся продукты питания. Влияние этого соединения на здоровье людей до сих пор не до конца изучено, но существуют опасения, что оно может быть вредным для младенцев, которых кормят молоком из пластиковых бутылочек и детским питанием из баночек. Научное название – полиоксиэтилен (20) сорбитан моностеарат. Этот эмульгатор используется в выпечке, чтобы она не деформировалась, для улучшения структуры теста и образования вкусной корочки. А еще чтобы хлеб не портился. Да-да, даже бактерии гнушаются этого соединения.
Научное название – полиоксиэтилен (20) сорбитан моностеарат. Этот эмульгатор используется в выпечке, чтобы она не деформировалась, для улучшения структуры теста и образования вкусной корочки. А еще чтобы хлеб не портился. Да-да, даже бактерии гнушаются этого соединения. Реннин используется в приготовлении сыров. Этот энзим получают из желёз сычуга (4-го отдела желудка) жвачных животных, и именно поэтому в некоторых странах, например, в Великобритании, сыры иногда считаются продуктами, непригодными для употребления вегетарианцами.
Реннин используется в приготовлении сыров. Этот энзим получают из желёз сычуга (4-го отдела желудка) жвачных животных, и именно поэтому в некоторых странах, например, в Великобритании, сыры иногда считаются продуктами, непригодными для употребления вегетарианцами. Бутилгидрокситолуол – это органическое вещество, используемое в качестве антиоксиданта в производстве самолетного топлива, смазочных масел и пищевых продуктов (всевозможных зерновых завтраков).
Бутилгидрокситолуол – это органическое вещество, используемое в качестве антиоксиданта в производстве самолетного топлива, смазочных масел и пищевых продуктов (всевозможных зерновых завтраков). Почему сладкая крошка на ваших любимых куличах или кексиках такая красная? Хороший вопрос. Оказывается, производители этого красителя собирают тысячи насекомых (кошенильных червецов) и варят их в аммиаке, а после фильтрации полученной смеси туда добавляют квасцовый порошок, и в итоге получается пищевой краситель кармин. Приятного аппетита.
Почему сладкая крошка на ваших любимых куличах или кексиках такая красная? Хороший вопрос. Оказывается, производители этого красителя собирают тысячи насекомых (кошенильных червецов) и варят их в аммиаке, а после фильтрации полученной смеси туда добавляют квасцовый порошок, и в итоге получается пищевой краситель кармин. Приятного аппетита. Ланолин еще иногда называют шерстяным воском или смазкой, поскольку это вещество вырабатывают домашние овцы, а используют его даже в производстве самых обычных жевательных резинок и различных косметических средств.
Ланолин еще иногда называют шерстяным воском или смазкой, поскольку это вещество вырабатывают домашние овцы, а используют его даже в производстве самых обычных жевательных резинок и различных косметических средств. В некоторых ресторанах это вещество применяют в качестве антислёживающего агента для чили. Если вы все еще помните школьную программу по химии, вы наверняка знаете, что более распространенное название диоксида кремния – это песок.
В некоторых ресторанах это вещество применяют в качестве антислёживающего агента для чили. Если вы все еще помните школьную программу по химии, вы наверняка знаете, что более распространенное название диоксида кремния – это песок. В качестве пищевой добавки цистеин можно встретить в муке. Широко его распространение также и в медицине. Ранее цистеин получали посредством гидролиза человеческих волос, но сегодня около 80% этой аминокислоты производится из утиных перьев.
В качестве пищевой добавки цистеин можно встретить в муке. Широко его распространение также и в медицине. Ранее цистеин получали посредством гидролиза человеческих волос, но сегодня около 80% этой аминокислоты производится из утиных перьев. Это химическое вещество можно встретить не только в мясных изделиях. Например, оно также является одним из основных компонентов в производстве пиротехнических изделий (порох, ракетное топливо, фейерверки). Кому колбаски?
Это химическое вещество можно встретить не только в мясных изделиях. Например, оно также является одним из основных компонентов в производстве пиротехнических изделий (порох, ракетное топливо, фейерверки). Кому колбаски? В Венесуэле и Колумбии есть страшная сказка о существе, проклятом целую вечность бродить по Земле с мешком костей за спиной.
В Венесуэле и Колумбии есть страшная сказка о существе, проклятом целую вечность бродить по Земле с мешком костей за спиной. Самые тревожные и страшные городские легенды часто появляются в азиатских странах, и многие из них впоследствии даже становятся основой для знаменитых фильмов ужасов.
Самые тревожные и страшные городские легенды часто появляются в азиатских странах, и многие из них впоследствии даже становятся основой для знаменитых фильмов ужасов. Мы привыкли, что в фильмах и на картинках лошадей изображают как прекрасных созданий и благородных животных. Однако если вы когда-нибудь окажетесь в Исландии и заметите там серую лошадь, стоящую на берегу моря или озера, сделайте себе одолжение и приглядитесь к копытам зверя. Если они смотрят в обратную сторону, то у вас проблемы – похоже, что вы повстречались с никсом…
Мы привыкли, что в фильмах и на картинках лошадей изображают как прекрасных созданий и благородных животных. Однако если вы когда-нибудь окажетесь в Исландии и заметите там серую лошадь, стоящую на берегу моря или озера, сделайте себе одолжение и приглядитесь к копытам зверя. Если они смотрят в обратную сторону, то у вас проблемы – похоже, что вы повстречались с никсом… Эта городская легенда гуляет по всему миру, но появилась она скорее всего именно в Норвегии. Много лет одна норвежская пара не могла себе позволить уехать в отпуск. Наконец-то все встало на свои места – супруги нашли надежную няню для своего подросшего малыша и запланировали путешествие.
Эта городская легенда гуляет по всему миру, но появилась она скорее всего именно в Норвегии. Много лет одна норвежская пара не могла себе позволить уехать в отпуск. Наконец-то все встало на свои места – супруги нашли надежную няню для своего подросшего малыша и запланировали путешествие. Самые страшные городские легенды – это страшилки, действие которых разворачивается ближе к нашим собственным городам и домам, или когда упоминание о них всплывает вновь и совсем недавно. Три года тому назад пользователь социальной площадки Reddit рассказал страшилку, которая ужасала его все детство и все его юношеские годы. Мужчина живет в Механиксвилле, штат Виргиния (Mechanicsville, Virginia), и в районе этого городка пролегает извилистая дорога под названием Стадли-роуд (Studley Road).
Самые страшные городские легенды – это страшилки, действие которых разворачивается ближе к нашим собственным городам и домам, или когда упоминание о них всплывает вновь и совсем недавно. Три года тому назад пользователь социальной площадки Reddit рассказал страшилку, которая ужасала его все детство и все его юношеские годы. Мужчина живет в Механиксвилле, штат Виргиния (Mechanicsville, Virginia), и в районе этого городка пролегает извилистая дорога под названием Стадли-роуд (Studley Road). В Южной Африке тоже есть свои городские мифы, и самые известные среди них – это история про Летучего Голландца и про призрачного попутчика с Юниондейл (Uniondale). Однако самая жуткая легенда зародилась здесь еще в 1887 году. Майор Альфред Эллис (Alfred Ellis) рассказал эту страшную сказку в своих «Южноафриканских очерках» (South African Sketches), и с тех пор легенда наводит ужас на всех местных жителей.
В Южной Африке тоже есть свои городские мифы, и самые известные среди них – это история про Летучего Голландца и про призрачного попутчика с Юниондейл (Uniondale). Однако самая жуткая легенда зародилась здесь еще в 1887 году. Майор Альфред Эллис (Alfred Ellis) рассказал эту страшную сказку в своих «Южноафриканских очерках» (South African Sketches), и с тех пор легенда наводит ужас на всех местных жителей. Как и Кровавая Мэри (Bloody Mary), Синий младенец – это легенда, связанная с зеркалом, только вот в случае с маленьким мальчиком в истории появляется еще и безумная мать, которая убила свое дитя осколком того самого зеркала. Естественно, после рождения жуткой истории появились и те, кто пытается призвать дух невинной жертвы, прозванной синим ребенком. Ритуал для встречи с потусторонним миром включает в себя поход в ванную в ночное время суток. Косметическое зеркало нужно запотеть так, чтобы на нем можно было написать «синий младенец». Свет в это время должен быть выключен, и тот, кто сделал надпись, должен сложить руки так, словно на них лежит настоящий ребенок. Поверье гласит, что дух мальчика непременно появится на руках призывающего его человека. Если по каким-то причинам вы уроните этого младенца на пол, ваше зеркало разобьется, а вы умрете.
Как и Кровавая Мэри (Bloody Mary), Синий младенец – это легенда, связанная с зеркалом, только вот в случае с маленьким мальчиком в истории появляется еще и безумная мать, которая убила свое дитя осколком того самого зеркала. Естественно, после рождения жуткой истории появились и те, кто пытается призвать дух невинной жертвы, прозванной синим ребенком. Ритуал для встречи с потусторонним миром включает в себя поход в ванную в ночное время суток. Косметическое зеркало нужно запотеть так, чтобы на нем можно было написать «синий младенец». Свет в это время должен быть выключен, и тот, кто сделал надпись, должен сложить руки так, словно на них лежит настоящий ребенок. Поверье гласит, что дух мальчика непременно появится на руках призывающего его человека. Если по каким-то причинам вы уроните этого младенца на пол, ваше зеркало разобьется, а вы умрете. Одним из самых жутких городских мифов Австралии считается рассказ о молодой женщине из городка Дарвин (Darwin), которую в районе Ист-Пойнта (East Point, прибрежная зона) изнасиловал японский рыбак. Когда девушка поняла, что она беременна, она пришла в ужас и повесилась на ближайшем дереве, которым оказался делоникс королевский.
Одним из самых жутких городских мифов Австралии считается рассказ о молодой женщине из городка Дарвин (Darwin), которую в районе Ист-Пойнта (East Point, прибрежная зона) изнасиловал японский рыбак. Когда девушка поняла, что она беременна, она пришла в ужас и повесилась на ближайшем дереве, которым оказался делоникс королевский. Говорят, что серия мистических фильмов «Восставший из ада» (The Hellraiser) была снята под вдохновением от ужасающей городской легенды, гудящей на всю Америку. По слухам в Луизиане (Louisiana, США) есть однокомнатный домик, стены которого покрыты зеркалами от пола и до самого потолка. Место получило жуткое название «Дьявольская коробка с игрушками» (Devil’s Toy Box), и согласно мифу, если зайти в этот дом и задержаться там слишком надолго, в комнате появляется дьявол и забирает душу несчастного.
Говорят, что серия мистических фильмов «Восставший из ада» (The Hellraiser) была снята под вдохновением от ужасающей городской легенды, гудящей на всю Америку. По слухам в Луизиане (Louisiana, США) есть однокомнатный домик, стены которого покрыты зеркалами от пола и до самого потолка. Место получило жуткое название «Дьявольская коробка с игрушками» (Devil’s Toy Box), и согласно мифу, если зайти в этот дом и задержаться там слишком надолго, в комнате появляется дьявол и забирает душу несчастного. Одна страшная японская легенда гласит, что спустя несколько лет после Второй мировой войны в Хоккайдо (Hokkaido) американские солдаты изнасиловали и избили местную девушку. Поруганная японка в тот же вечер спрыгнула с моста, стоявшего над железнодорожными путями, и ее сразу же сбил поезд. Тело несчастной перерезало пополам в районе талии. Погода в тот вечер была очень морозной, и поэтому девушка умерла не сразу. Медленно истекая кровью, она (ее верхняя половина) доползла до вокзала, где шокированный сотрудник станции набросил на жуткие останки кусок брезента. Самоубийца умирала в страшных мучениях.
Одна страшная японская легенда гласит, что спустя несколько лет после Второй мировой войны в Хоккайдо (Hokkaido) американские солдаты изнасиловали и избили местную девушку. Поруганная японка в тот же вечер спрыгнула с моста, стоявшего над железнодорожными путями, и ее сразу же сбил поезд. Тело несчастной перерезало пополам в районе талии. Погода в тот вечер была очень морозной, и поэтому девушка умерла не сразу. Медленно истекая кровью, она (ее верхняя половина) доползла до вокзала, где шокированный сотрудник станции набросил на жуткие останки кусок брезента. Самоубийца умирала в страшных мучениях. Египет всегда будет ассоциироваться со своими знаменитыми пирамидами, потому что эти гигантские строения впечатляют, особенно Великая пирамида Гизы. Около 5000 лет назад, вскоре после того, как фараон Хуфу (Khufu) взошел на трон, он понял, что его душе нужно место, где она смогла бы обитать вечно после его смерти. Все хорошие пирамиды были уже заняты, поэтому фараон велел построить для себя 138-метровое чудище, которое оставалось самым высоким искусственным сооружением на планете в течение почти 4000 лет.
Египет всегда будет ассоциироваться со своими знаменитыми пирамидами, потому что эти гигантские строения впечатляют, особенно Великая пирамида Гизы. Около 5000 лет назад, вскоре после того, как фараон Хуфу (Khufu) взошел на трон, он понял, что его душе нужно место, где она смогла бы обитать вечно после его смерти. Все хорошие пирамиды были уже заняты, поэтому фараон велел построить для себя 138-метровое чудище, которое оставалось самым высоким искусственным сооружением на планете в течение почти 4000 лет. Быстро перенесемся в 1700-е годы, и здесь пиво по-прежнему является движущей силой цивилизации. Пивоваренный завод Bass Brewery был основан в 1777 году, и к 1890-м годам он стал самой известной пивной компанией в Англии и крупнейшей в мире, производя ежегодно около 238 млн. л. напитка. Однако вы можете приготовить самое популярное в мире пиво 19-го века, но есть важный момент, который должен заставить клиентов купить именно ваш продукт – узнаваемость бренда.
Быстро перенесемся в 1700-е годы, и здесь пиво по-прежнему является движущей силой цивилизации. Пивоваренный завод Bass Brewery был основан в 1777 году, и к 1890-м годам он стал самой известной пивной компанией в Англии и крупнейшей в мире, производя ежегодно около 238 млн. л. напитка. Однако вы можете приготовить самое популярное в мире пиво 19-го века, но есть важный момент, который должен заставить клиентов купить именно ваш продукт – узнаваемость бренда. На пивоваренном заводе Bass Brewery решили, что для их пива необходима визуальная идентификация, какой-то понятный и четкий знак, указывающий на то, что продукт принадлежит пивоварне. К этому вопросу нужно было подойти очень серьезно, поскольку уровень грамотности был низким, но даже необразованные люди должны были распознать напиток Bass Brewery, когда они его увидят. В результате было решено использовать как основу красный треугольник, под ним написать «Bass», и поместить это знак на все продукты завода, что и стало самым первым применением логотипа.
На пивоваренном заводе Bass Brewery решили, что для их пива необходима визуальная идентификация, какой-то понятный и четкий знак, указывающий на то, что продукт принадлежит пивоварне. К этому вопросу нужно было подойти очень серьезно, поскольку уровень грамотности был низким, но даже необразованные люди должны были распознать напиток Bass Brewery, когда они его увидят. В результате было решено использовать как основу красный треугольник, под ним написать «Bass», и поместить это знак на все продукты завода, что и стало самым первым применением логотипа. Примерно в то же время, когда был основан завод Bass Brewery, любознательный английский химик по имени Джозеф Пристли (Joseph Priestley) работал над изданием более 150 работ, по науке, теологии, политики и философии. В 1767 году он поселился по соседству с пивоварней в Лидсе. Подогреваемый естественным любопытством, он заплатил за визит на пивоварню. Пристли был очарован газами, выделяемыми из чанов с пивом, и получил разрешение от пивоваров провести несколько экспериментов.
Примерно в то же время, когда был основан завод Bass Brewery, любознательный английский химик по имени Джозеф Пристли (Joseph Priestley) работал над изданием более 150 работ, по науке, теологии, политики и философии. В 1767 году он поселился по соседству с пивоварней в Лидсе. Подогреваемый естественным любопытством, он заплатил за визит на пивоварню. Пристли был очарован газами, выделяемыми из чанов с пивом, и получил разрешение от пивоваров провести несколько экспериментов. Пристли знал, что помещение живого организма в банку и лишение его воздуха – это смертный приговор, но он не знал, почему. Как жестокий ребенок, он любил класть пауков в банки и видеть, как долго они смогут продержаться до того момента, как их глаза перестанут блестеть, а ноги шевелиться. Продолжая свои кровожадные эксперименты, он поместил растение в банку и ждал, когда он умрет. Этого не произошло, более того, растение продолжало расти.
Пристли знал, что помещение живого организма в банку и лишение его воздуха – это смертный приговор, но он не знал, почему. Как жестокий ребенок, он любил класть пауков в банки и видеть, как долго они смогут продержаться до того момента, как их глаза перестанут блестеть, а ноги шевелиться. Продолжая свои кровожадные эксперименты, он поместил растение в банку и ждал, когда он умрет. Этого не произошло, более того, растение продолжало расти. В 1871 году немецкий инженер Карл фон Линде (Carl von Linde) опубликовал статью об улучшенных методах охлаждения, которая попались на глаза местным пивоварам. Для производства пива необходима низкая температура, поэтому его производство приходилось прекращать в теплые месяцы. Пиво – это дойная корова, которую пивоваренные заводы предпочитают доить постоянно, поэтому статья фон Линде привлекла большое внимание.
В 1871 году немецкий инженер Карл фон Линде (Carl von Linde) опубликовал статью об улучшенных методах охлаждения, которая попались на глаза местным пивоварам. Для производства пива необходима низкая температура, поэтому его производство приходилось прекращать в теплые месяцы. Пиво – это дойная корова, которую пивоваренные заводы предпочитают доить постоянно, поэтому статья фон Линде привлекла большое внимание. Скисшее, свернувшееся молоко – это печальная трата полезного напитка, но все было бы намного хуже без французского химика и микробиолога Луи Пастера (Louis Pasteur ). Его попросили помочь местному пивовару, который хотел выяснить, почему его пиво киснет. Ученый взял образцы из чанов, посмотрел на них под микроскопом и обнаружил тысячи микроорганизмов, которые, по его мнению, были причиной гниения, портившего пиво.
Скисшее, свернувшееся молоко – это печальная трата полезного напитка, но все было бы намного хуже без французского химика и микробиолога Луи Пастера (Louis Pasteur ). Его попросили помочь местному пивовару, который хотел выяснить, почему его пиво киснет. Ученый взял образцы из чанов, посмотрел на них под микроскопом и обнаружил тысячи микроорганизмов, которые, по его мнению, были причиной гниения, портившего пиво. Давайте вернемся к слухам о происхождении пива: какой-то сборщик оставил контейнер с сырым ячменем под дождем, в результате чего зерна начали прорастать.
Давайте вернемся к слухам о происхождении пива: какой-то сборщик оставил контейнер с сырым ячменем под дождем, в результате чего зерна начали прорастать. Сельское хозяйство – это не просто бросить семя в землю и ждать, когда что-нибудь вырастет. В этом есть много важных моментов. Фермеры должны знать, что растет, где, как долго, когда пришло время собирать урожай и другие важные моменты, связанные с ростом ячменя и производством пива. Как можно было следить за всем этим на заре человечества? Для этого подошла бы какая-нибудь система, позволяющая записать эту информацию, чтобы люди могли меньше полагаться на память и передачу из уст в уста, а больше на источник точной информации.
Сельское хозяйство – это не просто бросить семя в землю и ждать, когда что-нибудь вырастет. В этом есть много важных моментов. Фермеры должны знать, что растет, где, как долго, когда пришло время собирать урожай и другие важные моменты, связанные с ростом ячменя и производством пива. Как можно было следить за всем этим на заре человечества? Для этого подошла бы какая-нибудь система, позволяющая записать эту информацию, чтобы люди могли меньше полагаться на память и передачу из уст в уста, а больше на источник точной информации. Древние люди были кочевниками, но они не могли продолжать двигаться, не отказываясь от своей культуры и, следовательно, от сладкого пива. Настало время перемен. Люди должны были осесть на одном месте. Им нужно было построить больше постоянных убежищ. Эти убежища были тесно связаны друг с другом, потому что это облегчало взаимодействие в области сельского хозяйства. Похоже на город, не так ли?
Древние люди были кочевниками, но они не могли продолжать двигаться, не отказываясь от своей культуры и, следовательно, от сладкого пива. Настало время перемен. Люди должны были осесть на одном месте. Им нужно было построить больше постоянных убежищ. Эти убежища были тесно связаны друг с другом, потому что это облегчало взаимодействие в области сельского хозяйства. Похоже на город, не так ли?